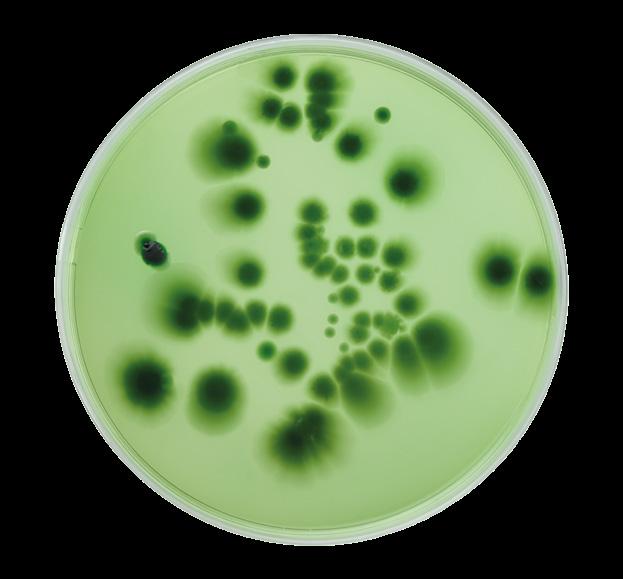

TIDNINGEN



![]()



Klapparna, recepten och djuren som gör julen

”Man
bråkar ju alltid om något på julen, varför inte om maten?”

GENOMBROTT EU utser ansvarig för djurskydd
KYCKLINGKOLL
Så många brister har slakterierna





JAG VILL SKICKA ett stort tack till dig som stått på djurens sida under 2024. Det är ditt stöd som gör det möjligt för oss att inte bara fortsätta vårt arbete utan också att våga sikta högre, tänka större och kämpa hårdare för djurens rättig-
heter. Och det behövs. Det här året har vi kunnat se återkommande exempel på när ekonomiska vinstintressen prioriteras framför djurskydd. Ett sådant tillfälle var när regeringens utredning om konkurrenskraft presenterades. Särskilt upprörande var förslaget om att slopa betesrätten för kor. Den starka mobiliseringen från djurvänner, djur- och miljöorganisationer och experter gör mig dock hoppfull om att framtiden för korna är ljus. På bara några månader höjde över 100 000 svenskar sin röst i vår kampanj för att försvara och utveckla betesrätten.

JAG ÄR OTROLIGT stolt över Djurens Rätts envisa och målmedvetna arbete med att skapa långsiktig förändring för djuren. Vi nöjer oss inte med att bara hantera dagens problem, utan arbetar hela tiden för att förbättra framtiden för alla de djur som är flest och har det sämst. Det innebär att vi ibland måste våga prova nya metoder, tänka större och bredare. Jag är stolt över att vi inte ger upp, oavsett hur stora hindren verkar vara, vare sig det gäller kampanjer mot stora livsmedelskedjor eller när det kommer till att flytta fram positionerna för djuren i politiken.
Men arbetet för djuren sker inte alltid i ramplju-
CAMILLAS
AGENDA
24 december: Jag firar en lugn jul med familjen, med grönt på julbordet och djurvänliga klappar under granen. Hoppas du också får en fin jul!
7 december: Årets sista möte med riksstyrelsen äger rum i Stockholm, där vi diskuterar det kommande årets arbete för djuren och utvärderar året som gått.
set. Ofta är det ett enträget arbete bakom kulisserna, där förhandlingar, möten och påverkansarbete pågår, varje dag – året om. Det är inte alltid tacksamt, men det är just sådana insatser som ofta ger de största och mest varaktiga resultaten. Även om dessa framsteg ibland kan kännas små i stunden, är varje förändring ett steg närmare en värld där djur behandlas som kännande individer.
DU KAN LITA på att Djurens Rätt kommer att fortsätta göra det som krävs för att skapa störst skillnad för flest antal djur. Vi kommer aldrig att sluta kämpa för en värld där djur respekteras som kännande individer med rätt till sina egna liv. Med ditt fortsatta stöd är jag övertygad om att vi kan nå dit. Tillsammans kan vi skapa en framtid där djurens behov inte längre får stå tillbaka för vinstintressen. Jag hoppas att du fortsätter att stå med oss i den här kampen, så att vi tillsammans kan göra 2025 till ett ännu bättre år för djuren. ●
15–16 februari: Det är dags för årets höjdpunkt, rikskonferens med alla Djurens Rätts fantastiska volontärer!
Agenda
07 Väntans tider. Försenad lagstiftning från EU är på gång.
08 Genombrott. EU utser en djurskyddskommissionär.
09 Kampanjkollen.
10 Granskning. På slakterifronten intet nytt – fortsatt enormt lidande för kycklingarna.
12 Forskningskollen. Ny ledtråd för att läsa hönornas känslor.
13 Budgetbesvikelse. 3R-centret blir återigen utan pengar.
14 Regeringens utredning. Folkstorm efter förslaget om slopad betesrätt – finns ännu fler förslag på försämringar.
16 Framgång. Fortsatt nergång för pälsbranschen i Europa.
17 Djurnyheter i korthet.
18 För julegrisarna. Hon försöker forska fram bättre bedövningsmetoder inför slakt.
20 Bäst i test. Ica är kedjan med störst vegoutbud – i år igen.
22 Fiskelycka. Fastän kunskapen om fiskars fantastiska förmågor växer, så är fiskvälfärden fortfarande på botten.
Välj Vego!
35 Godare jul. Prisbelönta Mattias Kristiansson bjuder på recept som får dig att vinna vegodebatten vid julbordet.
42 Till önskelistan. Julklappstips och juliga vegofavoriter.
44 Julnötter. Gör kunskapstestet som garanterar djuriga samtalsämnen under julen.
46 Djurvänligt företag.
Agera
49 Succéturné. Så blev den rullande storsatsningen i Europa.
52 Gör skillnad. Möt djurvännen Ami som varit volontär i 25 år.
54 Året som gått. Här är viktigaste framgångarna för djuren.
57 #DjurensRätt.
58 Insektsfabriker. Experten Cecilia Mille vet mer.
60 Expertsvar. Vilket djurvänligt budskap övertygar bäst i jul?
62 Det hände sen.







Redaktionsfrågan: Gott om julklappstips i detta nummer. Vad vill du ha under granen?
JOSEFIN STRANG, redaktör [Clavinova CLP] BENNY ANDERSSON, ansvarig utgivare [lego] AGNES DUNDER, art director [britpop på vinyl]
REBECCA JOHANSSON, Välj Vego-redaktör [upplevelser] LINN ÅKESSON, skribent [löparskor] MATILDA ANTTI, skribent [biobiljetter] NANNA THYDÉN, skribent [robotdammsugare]
THEA FAHLBERG, skribent [restaurangbesök & presentkort]
Frågor om Tidningen Djurens Rätt? Du når redaktionen på djr@djurensratt.se Vill du annonsera? Mejla annonser@ djurensratt.se
OM ORGANISATIONEN
CAMILLA BERGVALL, riksordförande, ordforande@ djurensratt.se
BENNY ANDERSSON, generalsekreterare, benny.andersson@ djurensratt.se
Frågor om Djurens Rätt eller ditt medlemskap? djurensratt.se info@djurensratt.se
08-555 914 00
Postadress: Box 171 32
104 62 Stockholm
Besöksadress: Hornsgatan 123 117 28 Stockholm
Plusgiro: 90 10 87-7
Pressärenden: 070-649 20 41 press@djurensratt.se
Vill du ändra din adress?
Gör ändringen direkt på djurensratt.se/adressandring eller ring 08-555 914 40.
Vill du bli medlem?
Besök djurensratt.se/medlem eller ring 08-555 914 00. Tidningen ingår i medlemskapet, prenumeration kostar 200 kr/år. Tidningen finns även som taltidning och bläddrings-pdf.
Materialet i tidningen publiceras även på webben. Återpublicering kan också ske i bok eller annan trycksak. Den som medverkar i tidningen med text eller bild anses normalt medge detta inom arvodets ram. Läsarbrev är välkomna men arvoderas inte och kan redigeras. För obeställt material ansvaras ej.
Tryck: V-Tab
ISSN 0345-2409 Årgång 122










Den efterlängtade översynen av EU:s djurskyddslagstiftning skulle ha presenterats hösten 2023, men så blev det inte. I samband med sveket utlovade EU-kommissionens ordförande Ursula von der Leyen en "strategisk dialog om framtiden för EU:s jordbrukspolitik". I dialogen, som nu genomförts, deltog 29 stora aktörer som enades bakom en rapport som nu har landat på EU-kommissionens bord. Resultatet? Inget drömscenario, men bättre än väntat.
– Rapporten innehåller faktiskt flera ljuspunkter! Exempelvis är alla överens om att resten av översynen av EU:s djurskyddslagstiftning, inklusive en utfasning av burar inom livsmedelssystemet, ska presenteras senast 2026. Det är såklart varken den tidshorisont som vi hoppades på eller blev lovade, men vi tror att det är bättre att specificera 2026 än att inte nämna något årtal alls, säger Matilda Antti, politiskt sakkunnig hos Djurens Rätt. Djurens Rätts förhoppning är att den nya djurskyddskommissionären (läs mer på nästa sida) och EU-kommissionen gör djurskydd till en central prioritering under mandatperioden.
– Förslagen om djurtransporter som lades fram i slutet på förra året måste vässas till i beslutsprocesserna, och de övriga områdena för lagstiftning – hållning av djur, slakt och djurskyddsmärkning – måste läggas fram så fort som möjligt. En farhåga kring lagstiftningen, förutom ännu en sprucken tidsplan, är sänkta ambitionsnivåer och omotiverat långa övergångsperioder, säger Matilda Antti. av Linn Åkesson
Antal underskrifter för inrättandet av en djurskyddskommissionär.

MÅLET ÄR NÅTT – snart har EU en djurskyddskommissionär. I oktober 2023 överlämnades 309 897 underskrifter till EU-kommissionen, i samband med kampanjen EU for Animals som bland annat drevs av Djurens Rätt. Kampanjen krävde att EU inrättar en djurskyddskommissionär för att säkerställa att djurens välfärd inte förbises av EU-politikerna. Nu, efter snart fyra års arbete, har EU-kommissionens ordförande Ursula von der Leyen meddelat att detta blir verklighet. En EU-kommissionär kommer att bära titeln kommissionär för hälsa och
Antalet år som Djurens Rätt arbetat mot det här målet.
Antalet kommissionärer i EU.
309 897 3,5 27 5
djurskydd, en titel som tidigare var kommissionär för hälsa och livsmedelssäkerhet
UNDER HÖSTEN 2023 skulle översynen av EU:s djurskyddslagstiftning ha presenterats. Översynen skulle bestå av lagstiftningsförslag som täcker fyra områden: djurhållning, transport och slakt, samt märkning av animaliska livsmedel i butiker. Av dessa utlovade paket presenterades endast förslagen om djurtransporter, som dessutom lämnade mer att önska. Mycket står på spel för djuren under den kommande mandatperioden. Att det är
tydligare vem som bär ansvaret för djurfrågorna är en bra början, anser Djurens Rätt. – Det är glasklart att EU-medborgare inte får gehör för sitt starka engagemang i djurfrågor. Om så varit fallet, hade knappast en majoritet av framgångsrika medborgarinitiativ berört djur. Engagemanget går dock inte EU-kommissionens ordförande Ursula von der Leyen obemärkt förbi och jag tror att hon, särskilt efter förra höstens brutna löften, kände att det var på tiden att ge vår rörelse något, säger Matilda Antti, politiskt sakkunnig hos Djurens Rätt.
DEN TILLTÄNKTA kommissionären är den kontroversiella ungraren Olivér Várhelyi, som är kompis med landsmannen Viktor Orbán. Under förra mandatperioden var Várhelyi kommissionär för grannskapspolitik och utvidgning, under
Så många år är mandatperioden.
Knappt ett år har gått sedan Djurens Rätts kampanj EU for Animals gick i mål – och EU har lyssnat. Nu inrättas en djurskyddskommissionär, första person att bära titeln ser i skrivande stund ut att bli den omtvistade ungraren Olivér Várhelyi.
den tiden skaffade han ovänner och skapade rubriker.
– Olivér Várhelyi fick svettas under utfrågningarna, och om han tillträder officiellt hoppas vi att han gör djurskyddsfrågorna till en ännu mer central del av sitt uppdrag. Men oavsett person ser titeln ut att sitta säkert, och det är det vi firar –att Djurens Rätts hårda arbete gav utdelning och att djuren får bättre representation i EU, säger Matilda Antti.
SVERIGE DÅ? En djurskyddsminister är högt på Djurens Rätts önskelista. Inför valet 2022 överlämnades över 35 000 underskrifter till statsminister Ulf Kristersson (M), men kravet på inrättandet av en djurskyddsminister fick inget gehör. Den nya djurskyddskommissionären i EU tänder förhoppningen om en liknande förändring i den svenska politiken. av Linn Åkesson
Så går det för kampanjerna just nu – och så här kan djurvänner hjälpa till.
av Moa Oja Lindblad
Ny kampanj: Djurens kravlista 2025
Skriv under på djurensratt.se/krav2025

Det finns många djurskyddsproblem att åtgärda. Därför ska
Djurens Rätt uppmana regeringen att fatta viktiga beslut för djuren nästa år – i linje med den starka opinionen för bättre djurskydd. Det är dags att stoppa plågsam bedövning vid slakt, på hönor och minkar som hålls i trånga burar, mer resurser måste satsas på djurfri forskning och korna måste fortsatt få beta. Kravlistan lämnas över till regeringen i januari.
Stoppa bygget av bläckfiskfabriker
Skriv under på djurensratt.se/blackfisk
Planer finns på att bygga världens första bläckfiskfabrik i Spanien. Om den blir verklighet skulle cirka en miljon bläckfiskar lida och slaktas årligen. Företaget har fått många bakslag: demonstrationer världen över, underkänd miljökonsekvensutredning, och att delstaten Washington i USA ska förbjuda bläckfiskfabriker och inköp av sådan bläckfisk. Djurens Rätt uppmanar EU och spanska myndigheter att förbjuda bläckfiskfabriker.
Bevara och utöka beteskravet
Läs mer på djurensratt.se/jagvillbetanu
I augusti presenterades utredningen som föreslår att beteskravet slopas för kor i lösdriftsstallar, vilket skulle påverka åtta av tio kor i Sveriges mjölkindustri. Strax därpå överlämnade Djurens Rätt 110 927 underskrifter till landsbygdsminister Peter Kullgren (KD), från personer som kräver att beteskravet för alla kor ska bevaras och utökas. Djurens Rätts påverkansarbete fortsätter tills regeringen tagit ställning.



Kampanjkoordinator hos Djurens Rätt
Vad händer med Lidl?
I media
Djurens Rätts protester mot Lidl uppmärksammades av nyhetssajterna Foodmonitor, Nu, Dagens och MSN.

Kräv att företaget uppfyller löftet
Läs mer på djurensratt.se/kryssning
Norwegian Cruise Line antog en buräggsfri policy år 2016, men på grund av stora brister i rapporteringen är det svårt att bedöma om de faktiskt håller sitt löfte för hönorna. Kryssningsbolagets rapportering om utfasningen av burägg omfattar inte hela den globala verksamheten. Djurens Rätt har därför inlett en global kampanj för att företaget ska börja ta ansvar genom grundlig rapportering.
– Sedan 2019 har Djurens Rätt uppmanat Lidl att anta European Chicken Commitment (ECC) och sluta sälja turbokycklingar. Vi kommer inte ge oss. Det är på tiden att Lidl tar mer ansvar för kycklingarna och följer efter alla andra företag som redan påbörjat arbetet med ECC. Vi vill ha ett möte med Lidl och kommer att fortsätta ställa krav tills vi ser verklig förändring. Trots att kampanjen har pågått länge ser vi ett stort engagemang. Över 29 000 personer har skrivit under namninsamlingen. Vi har satt upp affischer från Malmö i söder till Luleå i norr. Mer än tusen personer har deltagit i vykortsaktionen, och våra ovärderliga volontärer dyker upp på protesterna gång på gång.
Varför Lidl?
– Vi vill att alla matkedjor i Sverige börjar jobba med ECC, men Lidl är den kedja som är störst i Europa med över 12 000 butiker. Det innebär störst förändring för de djur som är flest och har det sämst.
Stångas ni mot en vägg?
– Visst kan det kännas så, men vi vet att varje insats är viktig och att den tar oss ett steg närmre målet – att Lidl antar en ECC-policy. Även en stor och hård vägg brister till slut om du fortsätter att utsätta den för påfrestningar, och ibland lyckas vi orsaka små sprickor där ljuset skiner in.
Fyra av fem kontroller visade brister.
DJURSKYDDSBRISTERNA PÅ kycklingslakterier har kartlagts av Djurens Rätt för tredje året i rad. Lidandet för turbokycklingarna har fortsatt – fyra av fem kontroller visade brister. Granskningen genomfördes genom att begära ut kontrollrapporter från Livsmedelsverket samt länsstyrelserna i länen där de största kycklingslakterierna finns. Det handlar om Kronfågel i Katrineholm, Guldfågeln på Öland, Torsåsen Fågelprodukter i Falkenberg och Atria i Sölvesborg. Bland de vanligaste bristerna finns klämda vingar och huvuden, hög dödlighet under transporter och allvarliga frätskador på kycklingarnas fötter.
MÖRKERTALET ÄR STORT. En betydande mängd information
har sekretessbelagts av myndigheterna för att skydda företagens ekonomiska intressen.
gör det omöjligt att säkerställa att varje individ är i god hälsa. Myndigheterna accepterar att upp till en procent av kycklingarna dör under transport, vilket kan innebära att hundratals kycklingar dör vid varje transporttillfälle – hundratusentals per år, säger Anna Harenius.
Rätts kartläggning av kycklingslakterier uppmärksammades av bland annat SVT Sörmland, Tidningen Syre, Miljö&Utveckling och journalisten Marcus
Trots detta står det klart att över 125 000 kycklingar under fjolåret utsattes för lidande av sådan omfattning att det klassificeras som brottsligt.
– Att Djurens Rätts kartläggning pekar på liknande djurskyddsbrister tre år i rad är fruktansvärt och visar tydligt att en systemförändring måste ske. Kartläggningen visar att de största kycklingfabrikerna aldrig kan följa djurskyddslagen som det är tänkt att de ska göra. Det är dessutom absurt att myndigheterna maskar djurskyddsbrister för att låta företagen plåga kycklingar i fred, säger Anna Harenius, Djurens Rätts sakkunniga etolog. Kycklingar transporteras trots sjukdom och skador. Kycklingar med frätskador under fötterna tvingas sitta trångt i transportburar i flera timmar innan de når slakteriet. Det är vanligt att kycklingarnas huvuden och vingar kläms i transporterna med stort lidande som följd.
– Det höga tempot och de stora mängderna kycklingar
ÅRETS KARTLÄGGNING VISAR att Kronfågel förblivit det värsta kycklingslakteriet två år i rad. Bristerna som Livsmedelsverket belyst har lett till att Kronfågel har tagit in extern rådgivning. Samtidigt finansierar Kronfågel forskningsstudier om tiden mellan bedövning och avblodning i syfte att få undantag från djurskyddslagstiftningen. – Slakterier som bryter mot djurskyddsreglerna måste drabbas av betydande sanktioner för alla de djur som de har utsatt för lidande. I dag verkar myndigheterna i stället ge tid för att företagen ska bättra sig, med risk för mer lidande. Politiker, företag och slakterierna verkar blunda för de fel som sker systematiskt, säger Anna Harenius.
Även vid slakten har allvarliga brister upptäckts. Kartläggningen visar att kycklingar har hittats utan att vara korrekt avblodade vid minst tre tillfällen under 2023, vilket innebär att de kan ha skållats levande. På Guldfågelns slakteri har en levande kyckling hittats i soporna, vilket tyder på stora brister i de interna rutinerna. I ett annat fall rapporterades ett haveri på samma slakteri, där tusentals kycklingar lämnades

utan tillgång till mat innan de slutligen slaktades.
ATRIA, SOM SÄLJER produkter under varumärkena Lagerbergs och Lönneberga, är Sveriges tredje största kycklingslakteri. Bristerna där tyder på att minst 67 000 kycklingar utsatts för lidande och misstänkta djurskyddsbrott – fler individer än vad som upptäckts på de övriga kycklingslakterierna. Trots att Livsmedelsverket informerat ansvarig länsstyrelse om bristerna så har det inte genomförts fysiska kontroller på slakteriet mellan 2021 och 2023.
80 %
Så många av kontrollrapporterna avslöjade brister på kycklingslakterier, utav de rapporter som Djurens Rätt fått tillgång till.


Vill du göra skillnad för kycklingarna? Det mest effektiva sättet att minska lidandet är att välja bort kycklingar från tallriken och i stället satsa på växt- baserade alternativ. Som medlem i Djurens Rätt stöttar du organisationens arbete för kycklingarna.
ENLIGT DJURENS RÄTT är djurskyddslagstiftningen inte tillräckligt stark för att skydda kycklingarna från lidande. Frätskador och hög dödlighet under transport är dessutom vanligare hos turbokycklingar, som dominerar i svenska kycklingfabriker. Utöver ett tydligare förbud i lagstiftningen mot avel som medför lidande, så arbetar Djurens Rätt för att få företag att minska inköpen av kycklingkött och att säga nej till turbokycklingar. – För att förbättra turbokycklingarnas situation
krävs en starkare djurskyddslagstiftning. På lång sikt krävs en systemförändring där djur respekteras som kännande individer med rätt till sina egna liv. Djurens Rätt uppmanar politiker och företag att ta ansvar och säga nej till turbokycklingar, men det viktigaste du kan göra för att säga nej till det här lidandet är att välja bort kycklingar från tallriken och välja vego, säger Anna Harenius. Tidningen Djurens Rätt har sökt kycklingföretagen för kommentarer, utan att få svar. av Nanna Thydén

Så
tycker Djurens Rätt
Det är viktigt att kunna läsa av djurs ansiktsuttryck för att vi ska kunna behandla dem bättre. Djur som människor tror är uttryckslösa, som fåglar och fiskar, behandlas i dag ofta sämre än däggdjur. Den nya studien belyser att de visar uttryck på sina sätt och att mer hänsyn behövs till varje individs stressnivå.
1,5 år
Vanlig livslängd hos hönor i äggfabriker. Hönor kan bli uppemot tio år gamla.
Visste du att hönor kan rodna? I en ny studie har forskare från Frankrike tagit reda på hur hönor ser ut när de är lugna och nöjda, jämfört när de utsätts för negativa upplevelser som vardagen i äggfabriker innebär. Forskarna kom fram
till att hönorna blir rödare i ansikte och kam när de upplever något negativt och stressfullt, exempelvis när de fångas in inför slakt. Men hönorna var också rödare när de var upphetsade över att få god mat. I kombination med hur fluffiga fjädrarna var i ansiktet kunde forskarna koppla fluffighet till nöjdhet, och rödhet till både positiv upphetsning och negativa situationer. Hönorna hade mest rodnader när de var rädda, vilket kan användas för att bättre förstå dem och undvika stressade situationer.
Källa: Arnould C. m.fl. (2024) Facial blushing and feather fluffing are indicators of emotions in domestic fowl (Gallus gallus domesticus). PLoS ONE 19(7): e0306601.
12 638
Antal hönor som är genomsnittet på en ekologisk äggfabrik.
8 miljoner
Mer än så många hönor utnyttjas i svenska äggfabriker.
VARJE HÖST PRESENTERAR regeringen en budgetproposition för kommande år. Därefter är det upp till övriga partier att lägga sina så kallade skuggbudgetar under den allmänna motionstiden. Tydligast skiljelinje sågs i frågan om 3R-centret. Sveriges 3R-center arbetar med att ersätta, minska och förfina användningen av djurförsök, sedan etableringen 2017 har centret finansierats med 15 miljoner kronor per år. Förra året försvann de öronmärkta pengarna i budgeten vilket ledde till att nio av tolv anställda fick gå. Nu, ett år senare, ekar skattkistan lika tom.
FLERA OPPOSITIONSPARTIER
vill återställa finansieringen.
Tre av fyra skuggbudgetar innehöll tydliga satsningar på Sveriges 3R-center. Socialdemokraterna budgeterar för den tidigare nivån på 15 miljoner, Miljöpartiet skjuter till 20 miljoner och Vänsterpartiet avsätter hela 40 miljoner. Centerpartiet öronmärker inga pengar till centret – tvärtemot vad partiet uppgav i Djurens Rätts enkät i våras. Även

Sverigedemokraterna uppgav i samma enkät att de ville återställa finansieringen, men inom deras budgetsamarbete med regeringen öronmärks alltså inga pengar till 3R-centret. – Samtidigt som det är beklagligt att regeringen inte tagit åt sig av den starka kritiken och återställt finansieringen, så är det mycket glädjande att se att övriga partier tar ställning för att inte bara återställa finansieringen, utan även öka den, säger Sebastian Wiklund, samhällspolitisk chef hos Djurens Rätt.
I ÅR INLÄMNADES över 3 000 fristående motioner under den allmänna motionstiden i riksdagen. Dessa kommer under
3 BUDGETBESVIKELSER FÖR DJUREN
1. Inga öronmärkta pengar till Sveriges 3R-center.

2. För lite pengar till djurskyddskontroller.
3. För lite pengar till arbetet mot smittsamma djursjukdomar.
våren att behandlas i utskotten, i regel kastas så gott som alla i papperskorgen. Att en motion tar sig vidare hör till ovanligheterna, men att lyfta frågorna är viktigt, och kan ge goda indikationer om var partierna står och om vilka vindar som blåser. Flertalet förslag lades fram som Djurens Rätt välkomnar, som rörde allt från att fasa ut uppfödningen av turbokycklingar till nationella mål för minskad köttkonsumtion. – Över tid kan vi se hur något som börjar som ett förslag från enskilda riksdagsledamöter blir hela partiets linje, för att sedan bli verklighet när partiet exempelvis hamnar i regeringsställning. Även om motioner sällan blir verklighet kan riksdagsledamöters engagemang under allmänna motionstiden säga mycket om vad som kan vänta runt hörnet, säger Sebastian Wiklund. av Matilda Antti
till mindre än en tredjedel av dagens nivåer i Sverige, för djurvälfärdens skull. Samtidigt måste ett skifte från turbokycklingar till mer hälsosamma raser påbörjas, vilket också Efsa påpekar.
Kan ge sämre djurskydd.
Utredningen och regeringen vill se specifik EU-lagstiftning för bland annat får, kalkoner, unghöns, avelsdjur inom kycklingindustrin samt nötkreatur över sex månader. Djurens Rätt arbetar för att artspecifik lagstiftning ska införas. Problemet? Utredningen föreslår att EU-lagstiftningen ska ta
hänsyn till den svenska bilden av att djurskyddet för kycklingar är tillräckligt, även när det är trångt i kycklingfabriken. Anna Harenius är sakkunnig etolog hos Djurens Rätt. – I Sverige är det i dag tillåtet att hålla upp till 25 kycklingar per kvadratmeter i trånga fabriker – och utredaren menar att trängseln som kycklingarna tvingas leva i är något värt att skydda i arbetet med ny EU-lagstiftning. Det är galet. Enligt EU-myndigheten Efsa:s rapport från 2023 behöver beläggningsgraden minska
Jordbruksverket är den myndighet som ansvarar för att ta fram detaljerade djurskyddsbestämmelser, så kallade föreskrifter. De mer övergripande bestämmelserna finns främst i djurskyddslagen, men även i djurskyddsförordningen. Enligt utredaren bör Jordbruksverket få i uppdrag att minska det totala antalet föreskrifter på djurskyddsområdet och införa "ökad flexibilitet".
– Problemet är inte att det finns för många, för tydliga eller för skarpa djurskyddsföreskrifter. Tvärtom, säger Linda Björklund, sakkunnig etolog hos Djurens Rätt.
– Det finns ett alltför stort glapp mellan djurskyddslagens skrivningar och syfte, och djurskyddsföreskrifterna.
De detaljerade föreskrifterna i dag är många gånger alldeles för veka, eller saknas helt som till exempel vad gäller slaktföreskrifter för fiskar, och lever inte upp till lagens intention om främjad djurvälfärd och ett gott djurskydd. Alla har dessutom att vinna på att bestämmelserna är tydliga, inte minst är det viktigt för möjligheten att kontrollera att lagstiftningen efterlevs, säger Linda Björklund.
Djurens Rätt var en av de drivande organisationerna bakom

Kornas betesrätt hotas av utredningen. Landsbygdsministern Peter Kullgren (KD) vägrade ta emot de över 110 000 namnunderskrifterna som stöttat kampanjen Jag vill beta , som kräver att kornas betesrätt kvarstår.
succékampanjen End the Cage Age, som lett till att EU troligtvis förbjuder burhållning av lantbruksdjur i den kommande djurskyddslagstiftningen. Nu befarar Djurens Rätt att Sverige riskerar att hamna på efterkälken, eftersom regeringens utredning föreslår att ensamboxar för nyfödda kalvar ska undantas från burförbudet. – Kalvar i ensambox får hållas på så lite som drygt en kvadratmeter ända till åtta veckors ålder. De kan varken röra sig som de behöver, leka eller få sitt sociala behov tillgodosett. I dag börjar allt fler se fördelarna med att hålla kalvar i grupp eller par. Det finns rekommendationer inom branschen om att hålla kalvar i par eller grupp från några dagars ålder. Burhållning, inklusive att hålla kalvar i små ensamboxar ska
I media
Nyhetsmorgon, P3
Nyheter, Dagens ETC, lokaltidningarna Örebronyheter och Oskarshamns-Nytt lyfte
Djurens Rätts kampanj Jag vill beta . Djurens Rätt skrev en debattartikel i Altinget riktad till landsbygdsministern.

såklart bort, inte försvaras, säger Linda Björklund.
4
Föreslår virtuella elstängsel
Virtuella elstängsel är en teknik där betesdjur hägnas in med hjälp av GPS-halsband som ger ljudsignaler och elstötar om djuren går utanför ett definierat område. I dagsläget finns det ett generellt förbud mot att styra djur med el, med undantag för elstängsel. Regeringens utredning menar att även virtuella elstängsel borde undantas, men Djurens Rätt är kritiska till detta.
Djurens Rätt anser att det behövs mer information om hur tekniken påverkar djuren. Sveriges lantbruksuniversitets vetenskapliga råd för djurskydd har pekat på flertalet
risker, såsom att vissa individer får många stötar och har svårt att förstå vad stötarna betyder. Inlärningsförmågan skiljer sig mellan olika djurslag och mellan individer.

I dag är det endast tillåtet att jaga vildsvin utan tillstånd från länsstyrelsen. Utredningen föreslår att det ska bli tillåtet att bedriva skyddsjakt utan tillstånd på dovhjort, kronhjort och rådjur. Detta ska gälla för markägare och jordbruksarrendatorer med jakträtt. Risken enligt Djurens Rätt är en ökad och okontrollerad jakt, vilket leder till skadeskjutningar och ökad risk för omfattande lidande.
Konkurrenskraftsutredningen vill att det ska bli enklare för svenska lantbrukare att låna pengar. Därför föreslås en miljard kronor gå till statliga kreditgarantier (eller annat finansiellt instrument). Syftet är att animalieproducenter ska kunna utöka produktionen. – Djurens Rätt är starkt emot förslaget att främja utvecklingen av fler och större djurfabriker. Det här skulle även vara ännu ett sätt att cementera en orättvis spelplan där animalieproducenter och producenter av växtbaserad mat konkurrerar på olika villkor. Stöden inom livsmedelsproduktionen behöver stötta omställningen till mer växtbaserat, i stället för att som nu nästan uteslutande gynna djuruppfödning och foderproduktion till djur, säger Linda Björklund. ●

I SKRIVANDE STUND finns det som mest åtta minkfarmer kvar i Sverige. De inväntar ett utlovat avvecklingsstöd från regeringen, och ska enligt branschorganisationen Svensk
I media
I oktober publicerade Nerikes Allehanda en debattartikel från Djurens Rätt som kräver att regeringen håller löftet och avvecklar minkfar-
regeringen lovade avvecklingsstöd och en utredning om att förbjuda all pälsdjursuppfödning. Djurens Rätt har varit i kontakt med Regeringskansliet och fått svar från departementssekreterare Rickard Canestierna:
”Kommissionens handläggning har dragit ut på tiden men vi har en löpande dialog för att komma i mål så snabbt som möjligt. […] När det kommer till tillsättande av utredningar så har vi en intern process för detta som vi inte kan föregå.” Djurens Rätt är kritiska till att arbetet dragit ut på tiden, och kommer fortsätta att sätta press för att det blir ett heltäckande förbud mot pälsdjursuppfödning.
Project 1882 är Djurens Rätts namn utomlands, under 2023 startades verksamhet i Ukraina. Under hösten har den första strategiska framgången nåtts i Ukraina. Det gäller den populära köp- och säljplattformen OLX, som efter dialog med Djurens Rätt har lovat att stoppa försäljningen av vilda djur på plattformen.
Djurens Rätts etablering i Ukraina inleddes med insatser för att undsätta, vaccinera, sterilisera, ge veterinärvård samt utfodra tusentals hemlösa djur som drabbats av kriget. Verksamhetschefen Hanna Tereshko var glad över att samarbetet med lokala organisationer kunde komma igång så snabbt.
Mink avsluta sin verksamhet innan årsskiftet. Det innebär med stor sannolikhet att Sveriges sista minkvalpar har fötts och dödats.
Det är nu över ett år sedan
SAMTIDIGT HAR ANTALET djur som föds upp för päls minskat i hela Europa. Det tydliggör att ett kommande förbud inte kommer leda till att pälsfarmer flyttar till ett annat land. I Finland, som har hundratals mink- och rävfarmer, har antalet farmer minskat kraftigt på grund av smittrisker. Nu satsar samhället på grön energi, solceller har anlagts på gamla tak till de nedlagda pälsfarmernas skugghus. Under oktober kom också nyheten att Rumänien förbjuder pälsdjursuppfödning från år 2027. Just nu pågår dessutom en lagstiftningsförhandling i Polen som kan leda till ett förbud framöver. All avveckling av pälsdjursfarmer i Europa kommer att främja medborgarinitiativet Fur Free Europe, som under 2026 förväntas kunna leda till förslag om ett EU-omfattande förbud av pälsdjursuppfödning samt handelsförbud av päls. av Anna Harenius
– Vi kommer att fortsätta vårt arbete med att bistå evakuering av djur från frontlinjen och kriget. Samtidigt som vi också kommer att bygga för framtiden och skapa förutsättningar för ett mer djurvänligt Ukraina, lovade Hanna Tereshko i fjol. Några av Europas allra största djurfabriker finns i Ukraina och över 750 miljoner turbokycklingar föds upp i landet årligen, dessutom är Ukrainas buräggsindustri enorm. Just nu pågår en översyn av Ukrainas strategi kring livsmedelsproduktion och Djurens Rätt deltar i diskussionerna.
av Josefin Strang

Snabb genomgång av läget i Djurens Rätts fyra prioriterade områden.
av Thea Fahlberg
Miljoner till vego-forskning
Kötthetsen trendar
Under sommaren har både Bulgarien och Malta beslutat att förbjuda uppfödning av minkar och import av levande minkar till landet. Det innebär att 13 EU-medlemsstater har ett fullständigt förbud, vilket tyder på att Europa är på väg bort från den plågsamma pälsindustrin.
Det saknas kunskap om växtbaserade proteiner och hur de påverkar människors hälsa. Nu har ett nationellt forskningscentrum vid Örebro universitet fått ytterligare 40 miljoner kronor i forskningsfinansiering. Pengarna ska användas till att ta reda på hur människor bryter ner växtbaserat protein i tarmarna.
Stödpaket mot sjötransporter
Under de kommande fem åren planerar Australien att fasa ut exporten av levande får till sjöss. Målet är slutdatumet den 1 maj 2028. För att hjälpa företag att anpassa sig till denna förändring så kommer den australiska regeringen att erbjuda ett stödpaket värt över 750 miljoner kronor.


I sociala medier har karnivordieten blivit allt mer omtalad, som i princip endast innehåller animalier som kött och mejeriprodukter, och inga växter. De bakomliggande, illa underbyggda argumenten är att karnivordieten ska vara bra för hälsan – men ingenstans framgår det hur karnivorkosten påverkar djuren som lider i djurfabrikerna.
tar mer än ger
En ny studie publicerad i oktober i Science Advances visar att fiskfabrikers påverkan på det vilda fiskbeståndet är större än tidigare uppskattat. Det mesta av vildfångad fisk blir inte livsmedel för människor – det blir foder till fiskar i uppfödningar. Dessutom bidrar fiskfabrikerna till spridning av sjukdomar och koldioxidutsläpp.
De vill återse
I år innehöll tre av fyra skuggbudgetar tydliga satsningar på Sveriges 3R-center som arbetar för att ersätta, minska och förfina djurförsöken. Socialdemokraterna budgeterar 15 miljoner, Miljöpartiet skjuter till 20 miljoner, och Vänsterpartiet vill avsätta hela 40 miljoner.
Rumänien förbjuder pälsfarmer
I slutet av oktober kom nyheten att Rumänien blir det sextonde EU-landet att införa ett förbjud mot pälsfarmer. Landets parlament har efter två år av politiska diskussioner röstat igenom ett förbud mot de två existerande pälsindustrierna i landet, som är mink- och chinchillafarmer.
3R utan pengar
Sveriges regering har tillsammans med Sverigedemokraterna för andra året i rad lagt fram en budget som saknar öronmärkt finansiering till 3R-centret. Inför 2024, när centrets finansiering på 15 miljoner försvann, fick nio av tolv anställda lämna verksamheten. 3R-centret är avgörande för att fasa ut djurförsöken.
Larmar om nya virus
I en studie från Uppsala universitet med flera upptäcktes 36 hittills okända och potentiellt farliga virus på kinesiska pälsdjursfarmer. Forskarna varnar nu allmänheten om att den dåliga djurvälfärden på farmerna kan leda till att pälsfarmerna blir nav för nya virus som sprids till djur och människor.

är en av dem som försöker hitta ett alternativ till koldioxidbedövning av grisar.
av Josefin Strang
foto
Pernilla Sjöholm

TJUGO ÅR HAR gått sedan myndigheter fastslog att koldioxidbedövning av grisar måste ersättas av djurskyddsskäl. Enligt djurskyddslagstiftningen ska djur skyddas från onödigt lidande, vilket är långt ifrån verkligheten för grisarna. Koldioxid används för att bedöva grisar inför slakt. Det tar omkring en minut för grisarna att förlora medvetandet, under den tiden orsakar gasen stark andnöd, smärta och rädsla. Trots det finns fortfarande ingen konkret förändring inom räckhåll.
ANNA WALLENBECK JOBBAR på Sveriges lantbruksuniversitet och är en av forskarna som försöker hitta alternativet till den plågsamma koldioxidbedövningen. Spåret som har mest potential ser ut att vara bedövning med kvävgas, forskningen har så här långt kunnat fastslå att kväve inte orsakar grisarna obehag.
– Vi som forskar ser potential, men tyvärr har jag fått känslan av att många tror att det här är den färdiga lösningen som kan implementeras storskaligt inom kort, säger hon. Haken är att kväve är lättare än luft, medan koldioxid är tyngre än luft.
– Det utnyttjas i dag genom att grisarna körs ner genom golvet i ett schakt med koldioxid. Om man tänker utanför lådan så skulle kanske en väg framåt vara att ha tekniska lösningar där grisen åker upp till kvävgas i taket. Vi har fortfarande inte testat kvävgasbedövning av grisar i slaktstorlek på kommersiella slakterier och det krävs mycket mer forskning och utveckling innan metoden skulle vara redo att implementeras i stor skala, säger Anna Wallenbeck.
HON BERÄTTAR ATT intressenterna är överens om att koldioxidbedövningen måste ersättas, men att det gnabbas om vem som borde finansiera forskningen av alternativa bedövningsmetoder.
– Att ersätta koldioxidbe-
dövningen har enormt intresse jämfört med andra forskningsområden – nationellt, internationellt, från allmänheten, politiker, forskare, industrin, slaktbranschen. Från politikers håll – nationellt och internationellt – brukar vi höra att utvecklingen av förbättrade bedövningsmetoder ska drivas av slakteribranschen och att skattepengar inte är den primära vägen att genomföra dessa förändringar. Så vad behövs tror du?
– Stora EU-satsningar för att få till tillräckligt stora, relevanta studier med internationellt forskningssamarbete. Vi behöver större innovationsprojekt. Frågan behöver vridas och vändas av biologer, samhällsforskare, etikforskare … Man kan driva på hur mycket som helst i ett enskilt land, men problemet kommer inte lösas nationellt, det här är ett internationellt viktigt område.
TVÅ DECENNIER HAR alltså gått sedan koldioxidbedövningen pekades ut som ett allvarligt djurskyddsproblem av EU:s myndighet för livsmedelssäkerhet (Efsa). I ett yttrande i maj 2020 bekräftade Efsa att ståndpunkten kvarstår. I juli 2024 gjorde myndigheten ett vetenskapligt utlåtande. – Ett steg i rätt riktning på den politiska arenan. Det är det största framsteget senaste halvåret, säger Anna Wallenbeck.
NÄR DET GÄLLER den plågsamma bedövningen vill Djurens Rätt se ett slutdatum för att sätta fart på forskningssatsningarna. De senaste åren har andra kuggar börjat röra på sig när det gäller grisarna. Köttkonsumtionen minskar från rekordnivåerna 2016, bland annat har branschföreningen Svenskt Kött kunnat konstatera att försäljningen av julskinka minskat med 20 procent de senaste tio åren. Under 2023 slaktades 2,5 miljoner grisar i Sverige, vilket är en minskning med fyra procent jämfört med föregående år. ●


Generalsekreterare hos Djurens Rätt
Vad är problemet? – Grundproblemet är att vi ser grisar som något vi kan lägga på tallriken. Att vi behandlar dem som snudd på känslolösa produkter i djurfabriker är konsekvensen av det synsättet. Det konkreta djurskyddsproblemet är att det är hemskt för grisarna att utsättas för gasen och hanteringen i samband med bedövningen. Koldioxiden gör ont att andas in och grisarna upplever stark stress, rädsla och andnöd. De kämpar för att ta sig bort från gasen. Det tar också lång tid innan grisarna till slut förlorar medvetandet.
Vad tycker Djurens Rätt? – Först och främst måste vi montera ner djurfabrikerna. Det här är ett ohållbart system där miljoner djur lider och dör helt i onödan. När det gäller bedövning vid slakt måste makthavarna sätta ner foten och omgående införa ett slutdatum för koldioxidanvändningen. En orsak till att den här metoden används, är att det går att slakta många grisar på kort tid eftersom de bedövas i grupp. Tid är pengar på slakterierna, därför eftersträvas en hög slakthastighet, vilket är otroligt cyniskt. Det minsta som kan begäras är att djuren utsätts för så lite lidande som möjligt. Där är vi inte i dag. Positivt är att fler och fler väljer bort kött till förmån för vego, vilket också är det mest effektiva sättet att hjälpa grisar på.
Rankingens resultat:
1. Ica
2. Willys
3. Hemköp
4. Coop
5. Lidl

ICA ÄR VEGOVÄNLIGASTE matkedjan. Det visar Djurens Rätts årliga kartläggning av matjättarna. Rankingen baseras på både butiksundersökningar och enkäter, där det växtbaserade sortimentet kartläggs i detalj. Ica kammar hem förstaplatsen med 200 poäng tack vare ett brett veganskt utbud. Sedan 2021, när rankingen började, har både inflation och globala händelser påverkat utbudet av växtbaserade produkter i butikerna. Ica har haft en ledande position under dessa år, men det är hos
kedjor som Lidl och Coop vi ser de största förändringarna i sortiment. Lidl, som fortfarande har det smalaste utbudet, har mellan 2023 och 2024 mer än fördubblat sitt sortiment av växtbaserade proteiner. Coop har en nedgång i vissa kategorier, men ståtar med ett av de bredaste utbuden av växtbaserade fisk- och skaldjursalternativ – vilket är särskilt viktigt ur ett djuretiskt perspektiv då det innefattar så många individer.
WILLYS, SOM HAMNADE på andra plats med 186 poäng,
Läs mer!
På Djurens Rätts hemsida hittar du hela rapporten Sveriges vegovänligaste matkedja 2024 .
visar en stabil utveckling över åren med ett konsekvent brett veganskt sortiment. Hemköp landade på tredje plats med 171 poäng, och även de visar en kontinuerlig tillväxt i sitt utbud av växtbaserade produkter.
Francesca Vilches är ansvarig för växtbaserad utveckling hos Djurens Rätt.
– Förhoppningen är att fler kedjor ska fortsätta att bredda sitt veganska sortiment och sätta tydliga, mätbara mål för sin utveckling. Enligt Djurens Rätts rapport finns det stor potential för ytterligare tillväxt inom detta område, både när det gäller proteinalternativ och växtbaserade mejeriprodukter, säger hon och fortsätter:
– Djurens Rätt ser med optimism på framtiden för växtbaserade livsmedel och hoppas att fler matkedjor sätter tydliga mål för att utöka sitt veganska sortiment och bidra till en mer hållbar matproduktion.
av Linn Åkesson
Hur ska hotell, restauranger och snabbmatsställen minska inköpen av animaliskt protein och i stället satsa på växtbaserade alternativ? Det är temat för Djurens Rätts färska rapport som släpptes under senhösten. Rapporten kan konstatera att flera företag ersätter rött kött med kycklingkött, vilket innebär att fler djur dödas och far illa i djurfabriker. Att byta ut en djurart till en annan är varken en djurvänlig eller hållbar lösning, anser Djurens Rätt. Rapporten rekommenderar målsättningar som leder till verklig förändring för djuren. Många företag har duckat, medan vissa har till följd av rapporten valt att sätta ambitiösa mål för att minska inköpen av kött. Linnea & Basilika och Hawaii Poké är exempel på företag som klivit fram och tagit ansvar. I samband med rapporten meddelade Scandic Hotels Group att deras mål hittills inneburit en 30-procentig minskning av animaliska proteiner. – Dessa mål kommer på sikt att minska antalet djur som föds upp i djurfabriker. För att skapa en framtid utan djurfabriker behöver fler aktörer inom livsmedelsbranschen ta sitt ansvar i den växtbaserade omställningen, kommenterar Nathalie Söderström, chef för företagsrelationer hos Djurens Rätt.



Vetenskapen om fiskarnas fantastiska förmågor har vuxit, dock utan att göra större avtryck hos allmänheten eller i djurskyddslagstiftningen. Fiskvälfärden är nere på botten men kuggarna har börjat röra på sig.


Du har hört berättelsen många gånger.
Encelliga organismer. Flercelliga organismer. Trilobiter. Fiskar. Amfibier som fick lungor och kravlade upp på land.
Reptiler. Däggdjur. Primater. Och till sist, skapelsens krona – homo sapiens, högst på evolutionstrappan. Ja, så låter människans malliga version av historien.
undersökning. Att fiskar gravt underskattas märker zoofysiologen Albin Gräns, som forskat om fiskvälfärd i snart 20 år.
– Hälften av svenska folket kollade på Blue Planet på söndagen, och när jag på måndagen föreläser om fiskar så förvånas åhörarna över att höra hur komplexa fiskar är. Det borde vara självklart!
SJÄLV ÄR ALBIN GRÄNS imponerad av en färsk studie med den blygsamma blå putsarfisken. De fick betrakta sig i speglar, uppfatta sin storlek och valde därefter att inte mucka med fiskar av större storlek. De till och med simmade tillbaka till spegeln för att dubbelkolla ögonmåttet.
– I arbetet skriver forskarna att den blå putsarfisken är den första arten, förutom människor, där man kunnat uppvisa den graden av självkännedom. En liten hund som mopsar upp sig mot en betydligt större och starkare hund är ett bra exempel på den art som inte besitter den förmågan, säger Albin Gräns.
För några år sedan blev det tjafs i forskarvärlden, i centrum av konflikten stod forskargruppen med de blå putsarfiskarna. Då hade fiskarna fått genomföra det klassiska spegeltestet. Först får djuret betrakta sig i en spegel. Därefter sätts en prick på en kroppsdel som djuret inte kan se själv. Sedan får djuret se sig själv i spegeln igen. Om djuret undersöker den främmande fläcken eller försöker gnida bort den på sig själv så har djuret klarat spegeltestet.
PÅ DEN HÄR tidslinjen får fiskar rollen som primitiva varelser, torftiga dumburkar med 530 miljoner år daterad hårdvara. Glädje, nyfikenhet, rädsla, ilska, frustration, smärta och lidande betraktas som moderna uppgraderingar förbehållna däggdjuren. I den här versionen av historien har klockan stannat i havet för 530 miljoner år sedan, men evolutionen har förstås fortsatt i både hav och på land. Fiskarna var faktiskt först med det senaste. Redan för 380 miljoner år sedan testade fisken materpiscis det här med graviditet – navelsträng och allt – men yttre befruktning skulle visa sig vara det vinnande konceptet för majoriteten av världens fiskar. Just nu finns 30 000 fiskarter beskrivna, toppen av ett isberg, och kunskapen om fiskarnas komplexitet har inte nått allmänheten. Ungefär tre av tio svenskar tror fortfarande att fiskar är oförmögna att känna smärta, enligt en färsk
Den blå putsarfisken ingår nu i ett mycket exklusivt sällskap som klarat testet, men som sagt, forskningen blev omtvistad. Linda Björklund som är sakkunnig etolog hos Djurens Rätt summerar saken: – Andra exempel på djurslag som klarat det här testet är elefanter, primater, delfiner, späckhuggare och skator. När putsarfisken klarade testet är det intressant att spegeltestet fick jättemycket kritik och testet ifrågasattes: "Är det relevant om en fisk klarar det?". Det säger mycket om människors syn på fiskar.
Den blå putsarfisken kan också peka på sin egen art på bild i utbyte mot en godbit. En liten smörbult har fotografiskt minne över undervattenstopografi som den simmat över en ynka gång. En guppy kan känna igen uppemot 40 andra individer i stimmet, enbart på utseendet.
– Många fiskar är väldigt sociala. De kommunicerar, leker, samarbetar, många fiskar lever i stora sociala grupper. Somliga tar hand om sina ungar, andra använder redskap. Det finns en broddfisk som använder stenar för att öppna musslor. En pansarmal och ciklid lägger ägg på blad för att kunna flytta äggen till säkrare platser, berättar Linda Björklund.
WHAT A FISH KNOWS
Intresserad av fiskars fysiologi och förmågor? Du får en introduktion i den här boken av etologiforskaren
Jonathan Balcombe, som fått många fiskätande läsare att tänka till.

BLUE PLANET
Den här förtrollande dokumentärserien från BBC är den mest ambitiösa skildringen av havets invånare. Två säsonger, 15 avsnitt, musik: Hans Zimmer, berättare: David Attenborough.
SIMMA LUGNT
ELLER SÄTTA FART
Webbinarium på Djurens Rätts Youtube-kanal. Få koll på aktuella problem inom fiskvälfärd och var politiken står i fiskfrågorna.

Liten, men klipsk. På senaste tiden har studier med speglar visat överraskande förmågor hos den blå putsarfisken. Reaktionen från omvärlden? Det måste vara fel på testen. "Det finns en föreställning om att fiskar skulle vara ett lägre stående djur, vilket inte stämmer. Evolutionen är inte en trappa från lägre till högre stående varelser, olika arter är helt enkelt anpassade efter olika miljöer", säger Linda Björklund, sakkunnig etolog hos Djurens Rätt.
MÄNNISKOR KLAMRAR SIG ändå fast vid föreställningen om att fiskar saknar smärtreceptorer, inte känner känslor och den envisa myten om guldfiskars usla minne. Det är kanske bekvämast så, med tanke på hur fiskar behandlas. I människans tidsålder är det kanske fiskarnas största nitlott att de inte haft nytta av att utveckla stämband. Att väsnas är

överflödigt under ytan, ljud färdas bättre i vatten, så det är vettigare att knorra och trumma genom att dra ihop simblåsan. Om fiskar kunde skrika hade fiske knappast betraktats som en fridfull fritidsaktivitet. En populär jämförelse är att sätta en äppelbit på en krok med lina, slunga ut den i skogen, släpa in en skrikande och sprattlande hare, för att sedan dränka den.
Albin Gräns.
– Fiskar kvävs i luften. Hos de flesta människor känns det inte lika starkt att se en fisk utsättas för något man rent logiskt vet orsakar lidande. Jämfört med när vi kanske ser en hund, ko eller kanin lida – där har vi lättare att känna empati, konstaterar Linda Björklund. Inte heller hade kommersiellt fiske tolererats. Det finns ingen djurskyddslagstiftning för vildfångade fiskar, så de kvävs i luften efter att de tagits upp eller dör i samband med att de strupskärs eller ren-

Syns det inte så finns det inte. I Sverige är bottentrålning den vanligaste metoden i kommersiellt fiske. När nätet släpas längs botten blir fångsten stor, men den lämnar kalhyggen på havsbotten. I juni meddelade regeringen planer på att skydda delar av Östersjön från trålning. "Problemen i Östersjön har varit kända sedan länge", konstaterade statsministern. Majoriteten av fiskarna från vildfångsten används senare som foder i djurfabrikerna.
sas, när de fortfarande är vid medvetande.
Många fiskar hinner inte så långt. Albin Gräns har nyligen avslutat ett forskningsprojekt till havs som kändes bedrövande.
– Vi försökte undersöka ett bra sätt att avliva fiskar som kommer upp i båten, men det visade sig att fiskarna redan var döda när de kom upp. De hade dött i trålen eller pumpen. Att fiskarna genomgått något utöver vad vi tidigare undersökt var tydligt, både utanpå och inuti fiskarna. I princip all fjäll hade skavts bort från deras kroppar. I blodproven kunde vi se att de röda blodkropparna fått utstå så pass kraftig stress att cellerna hade exploderat.
Bästa akutlösningen verkar vara fiske i mindre skala.
– Utvecklingen går mot ännu större trålare. Ju större trål och ju mer fisk som fångas, desto mer död fisk får man upp i båten. I den allra största fångsten, fick de enligt min uppskattning fem miljoner sillar i ett enda drag med trålen. Ungefär 96 procent var döda och det är möjligen en underskattning, säger Albin Gräns.
Ingen vet hur många fiskar som människan dödar, mellan tummen och pekfingret rör det sig om en–två tusen miljarder årligen. Det svindlande antalet är svårt att översätta till begripliga termer. Om varje fisk är lika lång som en sedel och du radar
upp dem på längden, så räcker raden med dödade fiskar till solen och tillbaka. Resan är så lång att den tar 16 minuter i ljusets hastighet. Trots sträckan får du ändå flera miljarder fiskar över.
EN UPPENBAR LÖSNING är att minska fiskkonsumtionen. Trots det vill svenska myndigheter se mer fisk på folkets tallrikar och undersökningar pekar på att svenskarna är sugna på att skruva upp fiskkonsumtionen. Samtidigt har överfisket blivit en allt mer brännande fråga. Så sent som i oktober spikades fördubblade fiskekvoter av strömming i Östersjön med kritikstorm som följd, även yrkesfiskare toksågade kvothöjningen. Så vad är svaret på ekvationen med mer fisk åt folket trots utfiskade hav? Jo, fiskuppfödning betraktas som lösningen. Framför allt regnar EU-pengarna över de landbaserade fiskfabrikerna, i Sverige finns flera stycken i startgroparna. – Det ses som en framtidsbransch värd att satsa på, men när det gäller djurvälfärden är fiskuppfödningar verkligen inte hållbara. Det är accepterat och belagt att djurvälfärd utgör en stor del av hållbarhet. Fiskuppfödningarna är intensiva djurfabriker med kala, karga miljöer som inte tar hänsyn till vad fiskarna behöver för att må bra, säger Linda Björklund.
● Att fiskar börjar ses och behandlas som de levande, kännande individer de är.
● Att fler ska välja växtbaserat i stället för fisk på tallriken.
● En stärkt djurskyddslagstiftning för fiskar på EU-nivå och i Sverige.
● Ett förbud mot koldioxidbedövning av fiskar vid slakt.
● Mer resurser till forskning om djurskydd vid slakt av fiskar.
● Att de fiskar som fångats inom fisket ska omfattas av djurskyddslagstiftningen.
● Att certifieringar av fiskprodukter ska inkludera relevanta kriterier om djurvälfärd.
● Nya kriterier om djurskydd och djurvälfärd i Upphandlingsmyndighetens kriterier om fiskar.
Skriv under Världens första kommersiella bläckfiskfabrik planeras på Kanarieöarna. Djurens Rätt driver en kampanj för att stoppa denna nya form av djurfabrik. Skriv under uppropet på djurensratt.se/ stoppa-blackfiskfabriker.

I en enda uppfödningskasse kan det finnas 200 000 laxar, som tillbringar två –tre år i trängseln. Fiskar i fiskuppfödning har rätt till bedövning inför slakt, men det finns inga bra sätt att bedöva och slakta fiskar storskaligt. I Sverige används den kritiserade koldioxidbedövningen, som är förbjuden i Norge sedan 2012. Koldioxidbedövningen är plågsam och leder ofta till att fisken paralyseras, men är vid medvetande när den skärs upp.

FISKAR I SIFFROR
75 %
Av all sjömatskonsumtion i Sverige utgörs av tio arter. Främst lax, men här ingår även torsk, sill och räkor.
62,8 miljoner
Så många laxar dog i förtid i norsk laxuppfödning. Utöver dem dog även 37,7 miljoner laxyngel tidigare i produktionsfasen.
1 miljard
Så många fiskar föds upp och slaktas varje år runt om i EU. Här är inte fiskgiganten Norge inräknad.
38 000 ton
Svenskarnas årliga konsumtion av lax från Norges laxodlingar, där var sjätte lax mår så dåligt att den dör i förtid.
Majoriteten av svenskars konsumtion av fisk- och skaldjur utgörs av tio arter, men konsumentundersökningar visar att folket vill bredda repertoaren. I Sverige finns långt gångna planer på att utöka uppfödningen av tilapia och clarias. Linda Björklund tycker det är absurt att fiskuppfödning får grönt ljus trots att det saknas både kunskap och lagstiftning om djurskydd för fiskar.

Laxen är en av arterna som äts mest, de flesta kommer från fiskfabriker i Norge. Under 2024 larmade norska myndigheter om djurskyddskatastrofen i laxkassarna till havs. Var sjätte lax hade dött i förtid av sår, infektioner och laxlusangrepp. Det motsvarar 63 miljoner döda, kasserade laxar på ett enda år i Norges laxuppfödning. Värre kan det bli. Årets värmerekord i Nordnorge har lett till en invasion av parasitlusen som kalasar i de trånga, kala laxkassarna. Avlusningsmetoderna är så våldsamma att laxar dör i drivor.
En mindre invasiv avlusningsmetod är att använda putsarfiskar – samma grupp fiskar som briljerade i de tidigare nämnda spegeltesten. Dessa putsarfiskar fångas i miljoner och hälls ner i laxuppfödningarnas främmande miljö, i hopp om att putsarfiskarna ska äta laxlusen. Även putsarfiskarna dör i drivor. Albin Gräns betraktar laxlössen och putsarfiskarna som det mest akuta djurskyddsproblemet inom fiskuppfödningen i vår del av världen.
– Hela den verksamheten är så märklig, med de förslavade fiskarna som mår så dåligt. Det finns vissa rapporter som säger att majoriteten av putsarfiskarna över huvud taget inte lär sig att äta löss. Om de stödutfodras så slutar många putsarfiskar att äta någon laxlus, så de verkar bara äta lus om
Det här gör Djurens Rätt
Djurens Rätt bedriver politiskt påverkansarbete för skärpt djurskyddslagstiftning i Sverige och EU. Viktiga förändringar är: förbud av koldioxidbedövning, att vildfångade fiskar ska omfattas av djurskyddslagstiftning och att fiskprodukter ska inkludera relevanta kriterier om djurvälfärd. Djurens Rätt informerar allmänheten om fiskarnas situation och om att de är levande, kännande individer med intressen och behov. Djurens Rätt driver även inspirationssajten Välj Vego som ska göra det lättare för fler att välja vego i stället för fiskprodukter.
de är utsvultna. Livet i laxkassarna är också en väldigt stressade miljö för putsarfiskarna, vilket är tydligt då de ofta drabbas av olika sjukdomar och infektioner.
GRISEN I GRISFABRIKEN slaktas efter ett halvår. Rekordtempot finns i kycklingfabriken, en turbokyckling når slaktvikt efter ynka fem veckor. Mindre känt är att laxfabrikerna har en ovanligt långsam gång. – Laxen är två–tre år gammal innan den till slut slaktas. Det kanske inte alla vet, att det rör sig om en lång tid i en miljö som verkligen inte tar hänsyn till laxens behov. Samtidigt är det ett kort liv med tanke på att laxen kan bli runt 15 år gammal i det vilda, säger Linda Björklund.
Laxen är i perioder av sitt liv en ensamlevande rovfisk, men trängs ihop i kassarna. Utrymme och utlopp för naturliga beteenden finns inte på kartan. Linda Björklund tycker att det är bedrägligt att laxuppfödning presenteras som hållbart. – Laxen är en rovfisk och behöver fisk i fodret. Därför bidrar laxuppfödning till överfiskade hav.
Majoriteten av fångsten i Sveriges kommersiella fiske hamnar aldrig på människors tallrikar. Det mesta blir djurfoder, enligt statliga forskningsinstitutet Rise. Linda Björklund tycker att dilemmat har en enkel lösning: att människor väljer vego. – Det finns andra delar av vattenbruk än djuruppfödning, till exempel att använda alger på fler sätt än vi gör i dag. Jag önskar man skulle lägga mer krut där i stället, det skulle vara hållbart ur ett bredare perspektiv än vad fiskfabriker någonsin kan bli. Det är ett under att man över huvud taget får föda upp och slakta fiskar, när det finns så många luckor i både kunskap och lagstiftning om fiskarnas välfärd och hållbarhet. Fiskar klumpas ihop när det rör sig om olika arter med vitt skilda behov.
IBLAND HAR Albin Gräns bisarra arbetsuppgifter. Hans forskningsgrupp försöker lösa en av de allvarligaste problemen inom fiskuppfödning – dessa fiskar har på pappret rätt till en snabb och smärtfri bedövning inför slakt, men i praktiken plågas de ofta under slakten.
– Allt man gör med slaktforskning är märkligt, på något sätt. Att stå en hel dag och klubba fisk för att ta reda på hur djuren ska få det bättre – den är inte alltid lättförklarad.

På vissa svenska anläggningar används fortfarande den kritiserade koldioxidbedövningen. Vattnet bubblas med koldioxid, fiskarna sänks ner i vattnet och får panik, det tar lång tid innan koldioxiden får fiskarna att
Linda Björklund
Laxen är den vanligaste fisken på svenskarnas tallrikar.
Så här är laxens liv i det vilda samt i fiskfabriken.
Startar livet med matsäck
Under sommaren har både Bulgarien och Malta beslutat att förbjuda uppfödning av minkar och import av levande minkar till landet. Det innebär att 13 EU-medlemsstater har ett fullständigt förbud, vilket tyder på att Europa är på väg bort från den plågsamma pälsindustrin.
Vilda laxar fortplantar sig i sötvatten. Äggen läggs på hösten i gropar på grusbottnar och kläcks på våren. När ynglen kläcks har de en gulesäck, som är likt en matsäck. De lever i gruset av näringen i gulesäcken i en–två månader. Sedan börjar laxungarna äta plankton, insekter, blötdjur och kräftdjur. De unga fiskarna lever tillsammans i familjegrupper i bestämda revir.

och transporteras sedan till kläckerier, där kläckning av yngel sker i tankar med sötvatten inomhus. Dödligheten på kläckerierna är hög. Enbart i norsk laxuppfödning dog 37,7 miljoner laxyngel under ett enda år.
Simmar långdistans i grupp
Efter födseln lever en lax 1–1,5 år i sötvatten innan den genomgår det som kallas för smoltifiering. Då förändras laxens fysik och beteende för att den ska kunna leva i saltvatten i stället. För att vara skyddad mot hungriga fiskar så simmar laxen i stim, sträckorna är upp till tre mil om dagen. Målet är havet, där det finns bra tillgång på mat (som är andra fiskar).
Laxen lever ensam under delar av sin livscykel och simmar långa sträckor. Laxen migrerar: efter ett till fyra år i havet tar sig laxen tillbaka till sötvattnet där den började sitt liv, för fortplantning. Laxen använder sitt välutvecklade luktsinne för att hitta tillbaka, men även sidolinjeorganet (som känner av strömningar och rörelser i vattnet) är viktigt.
En del vilda laxar dör kort efter att de fortplantat sig. De som överlever simmar ut till havet igen och kan upprepa fortplantningen upp till fyra gånger. En lax i det vilda kan bli omkring 15 år gammal.
Naturligt beteende
Efter 8 –18 månader, när de unga laxarna i kläckerierna ska ha genomgått smoltifieringen, flyttas de till så kallade kassar i havet. Det är väldigt viktigt att denna flytt sker vid rätt tidpunkt. I laxfabrikerna regleras ljus och temperatur för att påskynda smoltifieringen. Dödligheten hos laxar i Norge är hög direkt efter att de unga laxarna flyttats till kassarna.
I kassarna i havet hålls laxarna tills de har uppnått slaktvikten. Det är upp till 200 000 laxar i varje kasse, i Norge får det hållas 25 kilo laxar per kubikmeter. I kassarna är också fiskarna instängda i befintligt vatten, de kan inte flytta sig till annat vatten när de skulle vilja och behöva det. De kan inte heller komma undan från andra individer.
När den uppfödda laxen är omkring två–tre år är det dags för slakt, men fler än en femtedel av laxarna dör under uppfödningstiden. Fiskarna som slaktas transporteras till slakteriet, vilket är stressande och många dör i samband med det. Det förekommer också mobila slakterier. Vid slakt ska fiskarna bedövas innan de utsätts för strupskärning och avblodning.

De vanligaste orsakerna till den höga dödligheten hos laxarna i kassarna är konsekvenser av behandling av parasiten laxlus, gälsjukdom och sår som orsakas av bakterier. Gälsjukdomen ger fiskarna andningsproblem och kan bero på smittämnen eller dålig vattenkvalitet. Till höger ser du en närbild på laxlusen, som även sprids till vilda laxar. Världsnaturfonden avråder konsumenter från att äta lax från norska uppfödningar och rekommenderar även att avstå vildfångad lax.
stillna. Problemen slutar inte där. Fiskarna paralyseras men är vid medvetande, enligt studier som Albin Gräns jobbat med. Norge har förbjudit koldioxidbedövning och förlitar sig till stor del på el. Utöver att effektiviteten av en elbedövning varierar kraftigt mellan olika individer, så förknippas den också med skador på muskler och skelett (till exempel bruten ryggrad). Albin Gräns konstaterar att det fortfarande inte finns ett lindrigt sätt att avliva en fisk på. – Inte i någon slags större skala. Allt vi gjort visar att det behövs ett kraftigt slag mot huvudet, som måste träffa rätt. Det finns en vision för en större skala, men vi har inte kunnat testa om det faktiskt funkar när maskinerna ska köras vid full kapacitet. Om maskinen bara slår, utan att träffa huvudet och bedöva fisken, så har vi ett enormt djurskyddsproblem.
Landlevande djur kan inte behålla eller återfå medvetandet vid dramatiska blodförluster. Fiskars fantastiska fysiologi ligger dem i fatet, tyvärr. Deras kroppar är ofta anpassade för att klara längre perio -
”Vi har höga förväntningar om att det kommer ett förslag på lagstiftningar kring hållning, transport och slakt av fiskar.” – Linda Björklund
der med begränsad tillgång på syre. Även om fisken strupskärs och rensas kan den förbli vid medvetande.
FORSKNINGSRESULTATEN GER jämt dåliga nyheter: fiskarna mår dåligt av hantering och transporter under uppfödningen, fiskarna plågas under bedövning och slakt, det finns inga maskinerier på marknaden som garanterar fiskarnas välfärd. Trots de svåra förutsättningarna tror Albin Gräns att ett genombrott är nära, och att det kan leda till en snöbollseffekt.

– Med arterna tilapia och clarias, som blir allt vanligare matfiskar, så är vi inte så långt borta från att kunna visa upp ett bedövningsalternativ som funkar i stor skala. Om Sverige verkligen går i framkant och kan visa att det även kan fungera på en laxfisk som röding eller regnbåge, då skulle andra länder börja snegla mot oss ännu mer. Då tror jag utvecklingen skulle kunna börja röra sig mycket fortare.
Fastän Sverige är ett lilleputtland inom fiskuppfödning så har forskarna varit på hugget, studierna har gett ringar på vattnet i hela världen. Mikroframgångar finns, de kommer i snabbare takt och frågan är inte trögjobbad längre, enligt Albin Gräns. – Första kontakterna jag hade med branschen var runt 2012. Då var det rätt mycket stängda dörrar, nu är i princip alla positiva. Visst finns det en rädsla hos uppfödarna att få nya krav på sig som kostar massa pengar, men de håller med om att fiskarna ska ha det bättre och att vi ska ta reda på hur, säger han och fortsätter: – Medan vi håller på med forskningen
har vi fiskuppfödare, djurrättsorganisationer och myndigheter såsom Jordbruksverket som kikar oss över axeln och väntar ivrigt på resultaten. Och konsumenter, för den delen. Intresset är stort och arbetet känns meningsfullt.
Och det finns hur mycket som helst att göra. Nästa forskningsfråga som Albin Gräns vill dyka ner i är varför fiskar i landbaserade fiskuppfödningar lätt blir sköra och sjukliga.
– Anläggningarnas miljö hålls många gånger extremt stabil, såsom temperaturen och syrehalten, och fiskarna upplever inte heller några dygns- eller säsongsförändringar. Vi tror att detta kan skapa djur som är hyperkänsliga mot all typ av förändring, det vill jag utreda på ett bättre sätt. Det finns en anledning till att idrottare höghöjdstränar innan OS, genom att utsättas för variation i miljö blir de starkare. Så kanske det är med djuren också?
ÄVEN LINDA BJÖRKLUND är hoppfull trots allt. Hon har jobbat med fiskfrågorna ända sedan hon började hos Djurens Rätt för snart 20 år sedan. Inte många djurskyddsförbättringar för fiskar har hänt under den tiden, men hon anar nya strömningar. För vildfångade fiskar går det "väldigt trögt eftersom ingen vill ta ansvar" men snart väntas genombrott för uppfödda fiskar.
– När Djurens Rätt skrev vår första rapport om fiskar under 2008 var vi ganska ensamma om att fokusera på fiskvälfärdsfrågorna. Det har absolut skett en positiv förändring kring vilken uppmärksamhet fiskarnas djurskydd får. Från noll, till att fiskarna ofta är med i sammanhang där det pratas om djurskydd och välfärd för djuren som föds upp för livsmedelsproduktion, säger Linda Björklund.
Inom kort väntas Jordbruksverket presentera nya slaktregler där fiskar och skaldjur troligen ingår. Dessutom har EU lovat en ny djurskyddslagstiftning (som skulle ha presenterats 2023).
– Vi har höga förväntningar om att det kommer ett förslag på lagstiftningar kring hållning, transport och slakt av fiskar. Det händer saker, både nationellt och på EU-nivå. Det tar tid, men finns absolut ambitioner och vilja, säger Linda Björklund. Tiden är mogen. Nya opinionsundersökningar understryker att folket vill ha bättre djurvälfärd för fiskar.
– Att öka kunskap, medvetenhet, empati och förståelse för vad fiskar är för djur, det tror jag är jätteviktigt. Fiskar måste behandlas med den respekt de har rätt till och det handlar väldigt mycket om vad vi lägger på tallriken. Ett fint uttryck som vi kan göra till en minnesregel är att "fiskar är vänner, inte mat". ●
ASC är en hållbarhetsmärkning av fisk- och skaldjursprodukter från uppfödningar. Just nu arbetar ASC med att ta fram en märkning som ska inkludera djurvälfärd i kriterierna. ASC har redan tagit ställning mot bläckfiskfabriker. Eurogroup for Animals, en paraplyorganisation där Djurens Rätt ingår, arbetar med att ta fram välfärdskriterier för fiskar (inte olik den som finns för kycklingar, ECC).
Inom de närmaste åren väntas EU-kommissionen presentera den försenade översynen av djurskyddslagstiftningen, som ska bli nya lägstanivån i alla EU-länder. När utkastet läckte fanns flera förslag för fiskarna, så som välfärdskrav för bedövning av fiskar i vattenbruk. Utkastet lär urvattnas, men än finns stora förhoppningar om skärpta bestämmelser om fiskarnas välfärd. Ett av lagstiftningspaketen ska innehålla djurvälfärdsmärkningar av livsmedel – kanske våras det för en välfärdsmärkning av fisk- och skaldjursprodukter.

3 Nya svenska föreskrifter
Inom kort väntas Jordbruksverket presentera nya regler för slakt av en rad djurslag, troligen även fiskar. Mycket tyder på att det kommer regleringar om hur kräftor och humrar får avlivas, något flera andra länder redan lagstiftat om.
Fokus -
Djurvälfärden i fiskindustrin
lämnar mycket att önska.

Allt mer fisk som konsumeras av människor kommer från uppfödningar snarare än fisket. En anledning är att haven blir allt mer utfiskade. Men fisket och uppfödning av fiskar är nära sammankopplade, eftersom de uppfödda fiskarna behöver fisk i sitt foder – som fiskas ur havet. Fiskmjöl och fiskolja som används i fiskfoder tillverkas av så kallad foderfisk och av restprodukter från fiskindustrin. Av fiskarna som fångas i det svenska fisket används de flesta som råvara till foder. Även minkar på pälsdjursfarmer, höns, grisar, hundar och katter äter foder som innehåller fisk. Vanligaste fiskarna i Sverige som används till djurfoder är framför allt tobis, skarpsill och sill. Exempel på andra arter som fångas är torsk, gråsej, makrill, kolja, vitling och lax.
Fångstmetoderna, hanteringen efter fångsten och avlivningen orsakar stort lidande. Fångst med trål, nät, krok och andra redskap skadar och stressar fiskarna och innebär ofta en utdragen död. Fiskarna stressas och utmattas när de jagas och fångas. De krossas, kvävs och skadas av fångstredskapen och utsätts för dekompressionsskador när de tas upp till ytan. Även de fiskar som överlevt fångstredskapen möts av en utdragen och plågsam död. Vanligast är de kvävs i luften efter att de tagits upp ur vattnet, eller att de dör i samband med att de strupskärs eller rensas – när fiskarna fortfarande är vid medvetande. Det här är tillåtet, de vildfångade fiskarna omfattas inte av någon djurskyddslagstiftning. Det finns alltså inga djurskyddsregler om hur fiskarna ska hanteras och avlivas.
miljarder
Ungefär hälften (räknat i vikt) av människornas fiskkonsumtion kommer från fiskar från fiskuppfödningar. Mestadelen av fisken som föds upp och slaktas i svenska fiskfabriker exporteras till andra länder. De fiskarter som används mest för humankonsumtion i Sverige är lax, torsk och sill.
Cirka 50 –150 miljarder fiskar föds upp i fiskuppfödningar globalt per år. I Sverige rör det sig om fem –tio miljoner fiskar per år. Den dominerande fiskarten i svenskt vattenbruk är regnbåge. Andra fiskarter som föds upp är röding, ål, lax, öring, tilapia, clarias och stör. Uppfödning i nätkassar i öppna vatten är vanligast men det förekommer också uppfödning i dammar, bassänger eller tankar på land. Uppfödning i tankar eller bassänger på land i slutna, recirkulerande akvakultursystem (RAS) kommer allt mer. Den uppfödningen lyfts ofta fram som miljövänlig och hållbar, eftersom uppfödningen är avgränsad från omgivande vatten jämfört med uppfödning i kassar i sjöar eller hav. Ur ett djurvälfärdsperspektiv är dock bristerna och utmaningarna stora också i RAS-uppfödningarna. Utrymmet är litet, det är trångt och miljön är karg. Stora djurfabriker med laxar i sådana system planeras i Sverige.
Det finns ungefär lika många så kallade matfiskanläggningar (där fiskar hålls tills de ska slaktas) som sättfiskanläggningar i Sverige. På sättfiskanläggningarna föds de unga fiskarna upp och två olika öden väntar. Antingen transporteras fisken till en fiskfabrik för att födas upp för slakt, eller så sätts fisken ut i det vilda. Detta för att exempelvis kompensera för vattenkraftens inverkan på fiskarnas levnadsmiljö eller för att öka antalet fiskar som ska fiskas på en viss plats. Fiskarna från kompensationsuppfödningarna har låg chans att överleva i det vilda.
Både inom fiskuppfödning och fiske så räknas fiskarna i ton och inte antal individer, ingen vet hur många fiskar som fångas varje år. Uppskattningsvis är det omkring en till två tusen miljarder, det vill säga en –två biljoner fiskar, som fångas och dödas varje år globalt inom fisket. Omkring 150 000 –200 000 ton fiskar dödas varje år i det svenska yrkesmässiga fisket. Det motsvarar flera miljarder individer.
I fiskuppfödningarna kompromissas fiskarnas behov och välfärd. Problem finns bland annat kring uppfödningsmiljöns utformning, utfodring, utrymme och hänsyn till fiskartens sociala beteendebehov, risk för skador, sjukdomar, stress samt smärta i samband med hantering och transporter. Det är viktigt att ta hänsyn till varje arts specifika behov, eftersom de skiljer sig åt.
Viktiga parametrar att ta hänsyn till för förbättrad fiskvälfärd i fiskfabrikerna är:
● berikning av uppfödningsmiljön för ökade möjligheter till naturligt beteende
● fodrets sammansättning och utfodring
● utrymme och djurtäthet
● vattenkvalitet
● hantering
● avel
● bedövning och slakt.

Nästan all lax som äts i Sverige kommer från norska uppfödningar. I Norge dör runt en femtedel av laxarna i kassarna. Räknas laxarnas hela liv med så är dödligheten ännu högre. En av förklaringarna är parasiten laxlus, som i hög grad blivit resistent mot kemiska medel. Därför har andra metoder utvecklats, som spolning och behandling i varmt vatten som ofta är en dödlig påfrestning. Laxlusen bekämpas ofta med läppfiskar, en slags putsarfisk. Även dessa fiskar far mycket illa i laxfabrikerna, nästan alla putsarfiskar dör efter en kort tid där. Användningen av putsarfiskar är kontroversiell och problematisk på flera sätt. Årligen fångas flera hundra tusen läppfiskar från det vilda i Sverige och transporteras till Norge, där fiskarna som överlevt hanteringen och transporten sätts ut i laxfabrikerna. Flera tiotals miljoner läppfiskar används i laxfabriker i Norge varje år.
Ytterligare ett allvarligt problem när det kommer till fiskfabriker, är att slakten ofta är mycket plågsam. Det saknas både lagstiftning och kunskap på området, även om forskningen gör viktiga framsteg. I Sverige måste fiskarna bedövas, men fortfarande används den plågsamma koldioxidbedövningen som är laglig i Sverige men förbjuden i Norge sedan 2012.
Koldioxidbedövningen är ineffektiv och orsakar fiskarna starkt obehag och stress. Risken är stor att fiskarna inte bedövas utan utsätts för avblodning och rensning vid medvetande. Bättre bedövningsmetoder – om de används rätt – är elbedövning och slagbedövning, eller en kombination av de båda.
Det går dock inte att säga generellt vilken bedövningsmetod som är bra. För att lidandet ska minimeras är det av stor vikt att all bedövnings- och slaktutrustning samt hanteringen, är vetenskapligt testad och anpassad efter fiskens art och storlek. Fisken ska förlora medvetandet snabbt, inom en sekund, och inte återfå det. Det räcker inte att kontrollera visuellt om fisken är medveten eller inte, metoden måste vara utvärderad där fiskens hjärnaktivitet mäts.




Låt vegoveteranen Mattias Kristiansson guida dig till julens goda.

ÅRETS ELNA 2024: MOTIVERINGEN
Vinnaren av årets Elna Tenow-pris har visat ett outtröttligt engagemang i att främja och uppmuntra till en mer växtbaserad kost. Under Mattias Kristianssons ledning har tidningen Vego, Sveriges första och största vegetariska mattidning, inspirerat och utbildat en bred publik. Trots att Vego efter tio framgångsrika år nu har gett ut sitt sista nummer, så fortsätter Mattias arbete för djuren. Hans kokböcker finns i hem över hela landet, där de inspirerar människor med sina enkla men goda recept – och leder vägen mot en mer växtbaserad kost, måltid för måltid.

Om du ändå ska bråka på julen, varför inte bråka om maten?
Den numera prisbelönta vegoveteranen
Mattias Kristiansson
lovar att du övertygar genom krämig vegosill och julkryddiga vegobollar.
foto Oskar
Först, stort grattis! Djurens Rätt har utsett dig till årets vinnare av Elna Tenow-priset. Klassisk fråga – hur känns det?
– Det är jättekul! Jag blev väldigt chockad, sedan väldigt glad. Jag har aldrig vunnit ett pris tidigare! Aldrig! Och speciellt inte för jobbet jag gör, så det är stort.
Vilken djurrättsfråga ligger dig närmast hjärtat?
– För mig har det mest varit kycklingar, för att det är där som det är störst volymer och där det är mest slentrianmässigt på något sätt. Vissa djur är det som att människor bryr sig mindre om, och med kycklingar är det liksom ”de
med kycklingar och så är det bara en butik i hela landet, bara den här dagen. Som kommer att fyllas på om två dagar. Då inser man vilka volymer det är och hur meningslöst det är. Man kan ju uppenbarligen göra så god mat där man ersätter kycklingen! Just det här slentrian-köttätandet? Bort med det! ”Årets Elna” är en aktör som gör skillnad för djuren – hur har du lyckats med det genom din matlagning?
Du får publikfriande julrecept på nästa uppslag.
– Allt har ju handlat om att inspirera folk att äta mer växtbaserat. Det är ju grunden. Att göra det väldigt lättillgängligt och hela den biten. Sedan har jag ju valt att göra det med väldigt mycket, du vet, inga pekpinnar och mer vara den där trevliga vännen som inte dömer, utan bjuder med folk till butiken och säger ”kolla!”. Jag vill inte att folk ska känna sig ensamma i den här livsförändringen som de gör eller i kampen för djuren. Jag vill bidra till en form av ”community-känsla” och då är maten en väldigt bra brygga.
Sista numret av din tidning har kommit. Hur har vegovärlden förändrats dessa år?
kommer att hitta tillbaka, och snart kommer vi inte ha något val ändå för världen går under! Så det är bara att börja. Hur bryter man en köttvana? – Folk gör det många gånger väldigt svårt för sig själva, men jag tror enkel vardagsmat är nyckeln. Jag tror inte folk som inte är vegetarianer eller veganer fattar hur enkelt det är, eller till och med att det är enklare. Och billigare. Och bättre för klimatet. Men jag vill också att folk ska känna glädje i maten, för ett gott samvete är den bästa kryddan, och mat är mer än att du bara ska bli mätt. När man börjar se hur allting hänger ihop och hur maten påverkar allt omkring dig, då uppskattar man mat på ett annat sätt. Folk måste också släppa att mat måste vara så himla gott hela tiden! Jag vill bara normalisera helt okej god mat.
ser likadana ut, därför behöver vi inte bry oss”. Det tycker jag är obehagligt. När man går vid frysdisken och så ser man den där påsen med kycklingfilé, så tänker man: Här är sex kycklingfiléer, det är tre kycklingar. Sen så är hela frysdisken full
– Dels finns det extremt mycket produkter. Många av produkterna som många tar för givet i dag, fanns ju inte då. Sedan är folk mycket mer öppna. Det är verkligen jättestor skillnad, trots att vi aldrig fått mycket skit egentligen genom åren. Men jag har nog bara insett att saker går i vågor, och så får det vara. Sedan så tror jag att det kommer att vända. Det är väldigt turbulenta år nu och det är väldigt tydligt att det har förändrat folks vanor. Vi
MATTIAS KRISTIANSSON
Ålder: 39 år
Bor: Stockholm
Aktuell: Vinnare av Elna Tenow-priset, som är Djurens Rätts utmärkelse till en aktör som gjort skillnad för djuren.
Gör: Grundare av @vegomagasinet och håller nu på att ladda upp ”femtusen recept och alla artiklar” på sajten. Vill lansera sajten i Norden under 2025 för att han tycker att det går lite för långsamt, ”jag vill radera alla ursäkter för att inte äta växtbaserat”.
Bästa tips till vegonybörjare: Laga något du redan tycker om och ersätt animalierna. Håll det enkelt! Planera veckan så att du slipper stå i matbutiken och fundera.
Är julen verkligen rätt scen för att omvända köttätare? – Julmat är bra för att det är buffé, så man kan alltid få med någonting nytt. Folk kan äta kött, men de kan också testa nya grejer. På så sätt är det bra. Är det skitbra för att omvända till att käka vego i vardagen? Ingen aning. Jag tycker att julen är så groteskt köttig, men det kanske också är en bra start för samtal. Man bråkar ju alltid om något på julen, varför inte om maten?
Idiotsäkert juligt vegorecept? – Vegobollar! Det är en bra grej, för alla kommer att gilla det och ett bra koncept som alla fattar. Sedan gillar jag vegosillar överlag, speciellt i krämiga inläggningar. Då inser man att det inte handlar om sillen, det handlar om såsen. Inläggningar och vegobollar –det borde alla köra veganskt. Vad är planen – ska du vara julchef i år igen där du bestämmer över julmaten, julbakningen, pyntet och kör Mariah Carey på hög volym? – Inte Mariah Carey, men annars korrekt, ja. Jag bestämmer allt! Men det är ju för att det är det som jag är bäst på. Jag väljer bäst mat och jag lagar godast mat. Det är alla överens om. ●
Djurens Rätt
”Jag gick igenom så många olika klassiska recept på julköttbullar och resultatet ser du här. Formbar färs gör verkligen jobbet så enkelt, resten handlar bara om att smaksätta den på rätt sätt.”
INGREDIENSER
800 gram formbar vegofärs, exempelvis soja- eller ärtbaserad
2 gula lökar, finhackade
1 dl grädde, exempelvis havreeller sojagrädde
1 dl ströbröd
2 tsk dijonsenap
1 msk ljus sojasås
1 msk svamp- eller grönsaksfond
1 tsk mald kryddpeppar salt och svartpeppar
1. Tina vegofärsen. Enklast är att bara sprida ut på ett bakplåtspapper och vänta en halvtimme.
2. Fräs den gula löken i lite smör eller olja så att den mjuknar och börjar få lätt med färg.
3. Blanda under tiden grädde och ströbröd i en skål. Låt stå och svälla i 15 minuter.
4. Blanda nu färs, lök, ströbrödsmix och resterande ingredienser i en skål. Använd händerna, det blir enklast.
5. Rulla smeten till bollar och stek gyllene i lite mjölkfritt smör eller olja.


”Varje år försöker jag göra Janssons frestelse lite bättre. I år adderade jag fraiche för en lyxigare och syrligare känsla. I stället för ströbröd överst så körde jag på brödsmulor med smak av vitlök. Det passade verkligen så bra och är en ny favorit.”
INGREDIENSER
2 gula lökar, tunt skivade
2 msk mjölkfritt smör
1 kilo mjölig potatis
5 dl grädde, till exempel havreeller sojagrädde
2 dl växtbaserad fraiche
1 msk finhackad kapris
½ tsk mald kryddpeppar
1 tsk salt
Vitlökstäcke
4 skivor dagsgammalt bröd
50 gram mjölkfritt smör
1 vitlöksklyfta, riven eller pressad
1. Sätt ugnen på 200 grader.
2. Fräs den gula löken i smöret tills den mjuknar och blir lätt transparent.
3. Strimla potatisen fint och blanda med löken i en gratängform.
4. Vispa ihop grädde, fraiche, kapris, kryddpeppar och salt i en skål. Häll ner i formen.
5. Mixa brödet till smulor i en matberedare. Du kan även smula sönder det med händerna.
6. Smält smöret i en stekpanna och rör ner vitlöken. Vänd ner brödsmulorna och blanda väl.
7. Fördela brödsmulorna över din Jansson och gratinera i 50–60 minuter eller tills den har fått fint med färg.
Gör som över 31 000 andra och följ @valjvego för att få djurvänlig inspiration, kunskap, roliga tävlingar och de senaste produktnyheterna.
SAJT På valjvego.se hittar du en kunskapsbank för en mer djurvänlig livsstil. Här finns restaurang- och restips, recept, produktnyheter, fakta, allt.
Enjoy!
Få ett grönare och djurvänligare Facebookflöde genom att gilla Djurens Rätts systersida Välj Vego. Ta del av vegopepp, kunskap, utmaningar och vegonyheter.
MAGASIN
Vill du äta mer veganskt, men vet inte var du ska börja? Ladda ner Djurens Rätts nya, uppdaterade inspirationsmagasin Välj Vego! helt kostnadsfritt! Du får flera favoritrecept och får veta vad du ska äta varje dag för att få i dig allt du behöver.
APP
Vill du få tips i form av olika utmaningar som hjälper dig med recept, produkttips och annan inspiration? Ladda ner appen Välj Vego som finns kostnadsfritt i Google Play och App Store.
”Tofu är en hjälte när det gäller att dra åt sig smaker. Apelsin, ingefära och stjärnanis är en extra julig kombo som är svår att inte tycka om. Låt gärna tofun ligga till sig några dagar i lagen innan servering, så smakar den ännu mer.”
INGREDIENSER
100 g fast tofu
1 apelsin
2 rödlökar, tunt skivade
2 cm färsk ingefära, tunt skivad
2 st stjärnanis
Lag
2 dl vatten
1 dl strösocker
½ dl ättiksprit (12 procent)
1. Skär tofun i mindre bitar.
2. Halvera apelsinen och skiva den tunt. Ta bort kärnorna.
3. Varva tofu, apelsin, rödlök, ingefära och stjärnanis i en glasburk.
4. Koka upp ingredienserna till lagen och häll ner i burken. Låt svalna helt i kylskåpet.
”Aubergine är lite av en klassiker när det gäller ’vegosillar’, men här har jag i stället rostat zucchini som får en fast, fin konsistens. Har du färsk ramslök kan du mixa eller hacka ner den i såsen, men jag använder mig av torkad ramslök.”
INGREDIENSER
1 zucchini, cirka 150 gram
2 msk rapsolja
2 msk ljus sojasås
1 citron, rivet skal
1 msk citronsaft
2 dl växtbaserad fraiche
1 dl äggfri majonnäs
1 msk torkad ramslök
1 vitlöksklyfta, pressad salt och svartpeppar
1. Sätt ugnen på 175 grader.
2. Skiva zucchinin på längden i fem millimeter tjocka skivor. Lägg på en bakplåtspappersklädd plåt.
3. Vispa ihop olja och sojasås. Pensla zucchinin på båda sidor och rosta sedan i cirka 20 minuter eller tills zucchinin har mjuknat och fått färg.
4. Ta ut och låt svalna helt, skär sedan i mindre bitar.
5. Rör ihop resterande ingredienser i en skål. Vänd ner zucchinin.


”Man kan pickla så mycket goda grejer och fänkål är en av mina favoriter. Just den här smaksätts med dillfrön som jag älskar, men mortlade fänkålsfrön hade självklart också varit smarrigt.”
INGREDIENSER
300 gram fänkål
1 ½ dl vatten
1 citron, saften
1 dl strösocker
½ dl vitvinsvinäger
1 tsk dillfrön
1. Halvera fänkålen och skär bort roten. Skiva fänkålen så tunt du kan, enklast är att använda en mandolin. Lägg ner fänkålen i en glasburk.
2. Koka upp resterande ingredienser i en kastrull. Häll ner i glasburken och låt allt svalna helt i kylskåpet.
”Jag älskar krämiga inläggningar, speciellt med lite hetta som bryter av det feta i såsen. Här använder jag generöst med riven pepparrot som är så ruskigt gott att man blir kär.”
INGREDIENSER
150 gram fast tofu, smulad
2 dl växtbaserad fraiche
2 msk riven färsk pepparrot
1 citron, rivet skal och saft
2 msk röd tångkaviar
½ dl finhackad dill salt
1. Rör ihop samtliga ingredienser i en skål. Klart!
Trotjänaren tofu är en hjälte när det gäller att dra åt sig smaker. Ju längre tofun får gotta sig, desto bättre!
När julens smaker fyller din kropp och ditt sinne, får denna dessert faktiskt lov att ha storhetsvansinne.

Använd koden valjvego i Yvelis webbshop. Koden gäller till den 31 december 2024.

Av rapsvax från Sverige, ett doftande ljus, patchouli och cederträ fyller både hem och hus.
Ljuset det brinner i fyrtiofem hela timmar, miljövänligt & veganskt allra vackrast det glimmar. Patchouli & Cederträ –eterisk doft, 279 kronor på yvelis.se.

designat i Sverige men tillverkat brasilianskt.
Bältet Bo (495 kronor) och lågskon Olof (1 900 kronor) finns hos greenlaces.se.


Härligt krämiga och av finaste kvalitet, lyxiga praliner behöver inte vara en raritet.
Goda tryfflar i apelsin, kaffe och choklad, finns på Apoteket ända från Luleå till Mariestad. Apotekets chokladtryffel i smakerna naturell, apelsin och kaffe, 89 kronor styck på apoteket.se.
av Rebecca Johansson

Att beta av
En färdig klassiker i vegansk version, fixa en god jul utan större ambition. Gotländska rödbetor av bästa kvalitet, som du direkt på din vegobullemacka kan bre. Rydbergs veganska rödbetssallad finns i välsorterade butiker, 200 gram för cirka 16 kronor.
Julklappstips och julmatsfavoriter där julrimmet ingår!
Sotade ögon eller grafisk kant, eyeliner & mascara gör ögat så grant.
Veganska, parfymfria och ej testade på djur, två produkter som håller i både ur och skur.
Kit från IDUN Minerals med Mascara Vatn Volume 38°C & Creamy Eyeliner Lava, 299 kronor på idunminerals.com.

20 %
Använd koden JUL20 i Djurens Rätts webbshop.
ditt julfika
En havreboll så rund och gul, passar perfekt till myset i advent och i jul.

Njut av en fika med en härlig saffransmak, utan att ens behöva ställa till med ett julebak.
Delicato Lussebulleboll i sexpack finns i välsorterade butiker för cirka 39 kronor.

Tänk utanför presentboxen
Inget snack om saken
Ett plagg som säger det med klartext, att äta djur är konstigt, var snäll och ät en växt. Ekologisk och vegansk, gosig och mjuk, för finare tillfällen eller till vardagligt bruk!
Huvtröja från Djurens Rätt, 599 kronor på shop.djurensratt.se.

Ge bort en känsla i stället för en grej från en butik, liveupplevelser gör varje stund minnesvärd och unik. Med denna present får du glädje och energi, en julklapp fylld av magi, bättre kan det inte bli! Presentkort på valfri aktivitet till valfritt belopp.
1. På julen umgås vi ofta med långväga släktingar. Vilket av dessa djur är du mest lik, sett till arvsmassan?
A) Kyckling.
B) Zebrafisk.
C) Manet.
2. Precis som den mytomspunna ålen, så letar sig laxen tillbaka till sina barndomsvatten när det är dags att yngla av sig. Enkel väg kan resan bli över 300 mil lång. Färden är möjlig bland annat tack vare att laxar känner av jordens magnetfält, men vilket sinne är också oumbärligt för att lyckas hitta tillbaka?
A) Laxens fenomenala luktsinne, som överträffar hundars med råge.
B) Sidolinjeorganet, som känner av minsta lilla tryckförändring. På så vis hittar laxen havsströmmar som leder hem.
C) Synen. Laxen följer stråk med flora och fauna som liknar miljön från barndomen.
Behöver du lite tidsfördriv i jul eller samtalsunderlag för stela släktsammankomster?
Testa djurkunskaperna med dessa tio frågor.
3. Vilka av dessa djur finns det flest av i Sverige, under ett helt vanligt år?
A) Grisar i köttindustrin.
B) Kor i mjölkindustrin.
C) Hundar i hemmen.
4. Sillar formar havets mest spektakulära stim, tänk flera kubikkilometer med miljarder koordinerade, silverglimrande individer. Människor har sämre koll på att sillar har världens mest praktiska fisar – de används bland annat för att fly undan rovdjur. Vad har de enorma sillstimmens gaser misstagits för?
A) Läckage från gasledningen Nord Stream, som sträcker sig tvärs över Östersjön.
B) Fientliga ubåtar, vilket lett till att Sverige länge jagat ryska ubåtar i onödan.
C) Förvärrade (men felaktiga) miljö- och klimatmätningar av Östersjön.
5. En genomsnittlig svensk äter 213 ägg per år, konsumtionen exploderar under jul och påsk. För 15 år sedan satt 40 procent av Sveriges hönor i burar, men burarna är i stort sett borta nu. Varför?
A) År 1988 lovades Astrid Lindgren att burarna skulle försvinna, så branschen har anat ett förbud länge och därför slutat bygga nya burförsedda äggfabriker.
B) Tack vare medborgarinitiativet End the Cage Age, som Djurens Rätt varit med och drivit, så ska burägg fasas ut i hela EU senast år 2030.
C) Djurens Rätt har i 15 års tid uppmanat företag och konsumenter att sluta köpa burägg – under 2021 blev Sveriges livsmedelskedjor buräggsfria.
6. Hönsfåglar har ett rikt språk. Ibland händer det att en individ bluffar för att få uppmärksamhet, och ropar ”här finns det mat”. Hur behandlas bluffaren av hönsflocken?
A) Flocken visar orubblig tillit och smakar vad som helst som finns intill bluffaren.
B) Flocken börjar betrakta bluffaren som en lögnare och struntar i ropen framöver.
C) Höns har nolltolerans för lögner och ger bluffaren uppfostrande nyp med näbben.
7. I det här EU-landet har nio av tio kor utevistelse året runt. Vilket?
A) Sverige.
B) Portugal.
C) Irland.
Rätt svar hittar du längst ner på sidan.
8. Vilket påstående om grisar är falskt ?
A) Grisar har massor av nerver i trynet och sover gärna tryne mot tryne. Inte olikt människors känsliga händer och fingrar, och vår vilja att hålla händer.
B) Forskare har lärt grisar att spela tevespel. Fastän godisbelöningarna slutade komma så fortsatte grisarna att spela, troligen för skojs skull.
C) Under 2012 var svenskarnas konsumtion av griskött som lägst i modern tid. Sedan dess har konsumtionen av griskött i stort sett ökat varje år.
9. En turbokyckling når slaktvikt efter fem veckor – en bråkdel av artens potentiellt långa liv. Förra julen dog Peanut, en av världens äldsta hönor. Peanuts matte berättade att den gamla hönan snabbt blev skör efter att Peanuts dotter och pojkvän gått bort. Hur gammal blev Peanut? A) 13 år. B) 16 år. C) 21 år.
10. Stenhård avel har lett till att den typiska hönan i äggfabriken lägger 300 ägg per år. Hur många ägg lägger hönans vilda släkting, djungelhönsen i Asien?
A) Normalt mellan 20 och 30 ägg under sin livstid.
B) Ungefär 30 ägg per år. C) 80 ägg under hela sin livstid.
0–4 rätt: Nu har du gott om nya samtalsämnen att botanisera i vid halvtrista tillställningar i jul. Se hur ditt resultat står sig genom att utmana någon annan på testet.
5–8 rätt: Inte illa, testet spretar trots allt från laxars sinnevärld och sillstim till tevespelande grisar. Hoppas du lärt dig något nytt och nyttigt!
9–10 rätt: Det blir
A i solklart betyg. Du måste ha läst Tidningen Djurens Rätt pärm till pärm i åratal. Sträck på dig nästa gång du diskuterar djurvälfärd – du verkar väl påläst!
”Mer vego är rätt”
Linnea & Basilika-gruppen expanderar snabbt. I samarbete med Djurens Rätt ska företaget drastiskt minska inköpen av rött kött och kyckling. Tony Lindgren är färsk på jobbet och ansvarar för vegoresan.
Efter samtal med Djurens Rätt har ni valt att sätta vegomål. Har du hunnit komma i gång?
– Vi har hittills tre inbokade provlagningar med växtbaserade produkter tillsammans med olika producenter och leverantörer.
Varför vill ni minska försäljningen av kött?
– Vi ser att efterfrågan kommer till oss varje dag och

det går inte att blunda för det. Vi behöver inte nödvändigtvis vara den som leder tåget, men vi kan vara en förebild och en tillgång för den som behöver det. Jag har också varit i branschen länge nog för att ha sett skandal efter skandal inom animalieproduktionen. Mer växtbaserat är att gå åt rätt håll och dit är vi på väg!
Vad tror du blir roligast under resan mot målet?
– Att bli överraskad av hur långt producenterna av växtbaserat kommit när det kommer till smak och att ”äta med ögat”. Och mest utmanande?
”Jag har sett skandal efter skandal inom animalieproduktionen.”
– Den största utmaningen blir nog att få gäster som vägrar äta växtbaserat att våga prova på och se fördelarna. Och tyvärr prisbilden från producent, som kommer spegla sig i priset mot gäst till en början.

Läs mer!
I oktober släppte Djurens Rätt den sjunde företagsrapporten. Den kartlägger den växtbaserade omställningen hos några av Sveriges största hotell- och restaurangkedjor. Linnea & Basilika-gruppen (där A&M Sushi ingår) valde att sätta de mest konkreta och ambitiösa målsättningarna i samarbete med Djurens Rätt.
Har du några tips till andra företag som sneglar på samma målsättningar som era?
– En början är att ta hjälp från Djurens Rätt – med den expertisen så blir starten bra. Kolla runt på marknaden efter vad som finns just för eran verksamhet. Sedan sätta upp mål och fullfölja målet. Det är för kommande generationer som vi påbörjar denna omställning.
Hur har det varit att samarbeta med Djurens Rätt? – Sen jag fick möjligheten att ta vidare detta projekt som nyanställd inom Linnea & Basilika så har jag bara positiva ord för den uppbackning och hjälp jag fått – och kan få – av Djurens Rätt. ●



Fokus: Svenska välfärdsmyten TIDNINGEN
NR 3 / 2024






Ny utredning föreslår skrotad betesrätt på lammens nästa måltid



GÖR SKILLNAD!
Från Skandinavien ner till södra Europa och tillbaka igen. Succéturnén For the animals har folkbildat i 15 länder. Nu väntar nya hjulspår.
av Jennica Mayor Gustavsson foto Djurens Rätt

I media På sistone har turnén nämnts 24 gånger i internationella medier. Kroatiska och portugisiska medier har varit flitigast. Totalt har Project 1882 och Europaturnén nämnts i 69 artiklar och inslag. Här i Sverige uppmärksammades turnén av P4 Örebro.
Efter 21 stopp, 15 länder och sex månader var det dags att avrunda. Den första helgen i november gjorde lastbilen sitt allra sista turnéstopp för den här gången. Uppsala fick äran.
Så många inflytelserika
människor har besökt turnén, bland annat politiker, influerare och beslutsfattare i matbranschen.
856
Så många personer har besökt turnén For the animals under stoppen i sammanlagt 21 europeiska storstäder.
Så många gånger har Project 1882 och turnén uppmärksammats i media. I Lettland, Kroatien, Ungern och Portugal blev det extra stora medieuppbåd.

Djurens Rätt tog i maj 2024 klivet ut i Europa med turnén For the animals. Turnén startade i Helsingfors och fortsatte sedan genom Europa för att nå Lissabon som bortersta punkt. Under turnén har Djurens Rätt besökt 21 olika europeiska storstäder och samarbetat med 16 olika djurrätts- och djurskyddsorganisationer. Tillsammans har organisationerna förenat kunskaper och resurser för att maximera effekten vid varje turnéstopp.

Djurens Rätt har funnits sedan 1882 och är rutinerade i sammanhanget. Med turnén For the animals har lokala djurrättsorganisationer runt om i Europa fått hjälp på traven. Turnén har varit en sällsynt chans att kunna genomföra arrangemang som är svåra att slita blicken ifrån. Det är ju inte varje dag en många meter lång lastbil kommer lastad med interaktiva fakta om djurfabriker. – Europaturnén har stärkt banden mellan Djurens Rätt och organisationerna i Europa, vi jobbar för samma mål, en värld där djur ska behandlas bättre. Vi blir ännu starkare och tillsammans skapar vi en europeisk enhet för att förbättra livet för de miljarder djur som lider i Europas djurfabriker, säger Coral Ricote, kampanjchef hos Djurens Rätt.
Djurens Rätt kommer att fortsätta utveckla satsningarna på internationellt påverkansarbete.


Missade du turnén?
Du hittar Djurens Rätt på flera julmarknader i år:
30/11-1/12 Mitt Möllan, Malmö.
7- 8/12 Jul i Haga, Göteborg.
7- 8/12 Schysst Jul, Stockholm. 3/12 firas Giving Tuesday och Djurens Rätt kommer finnas på plats i Mölndal Galleria och Jakobsbergs centrum.
Suggor som fixeras i burar, kalvar som hålls isolerade från födseln och långa transporter av levande djur över landsgränser och hav. Det är några av många brister i djurskyddslagstiftningen. Under turnén har Djurens Rätt samlat in underskrifter från europeiska medborgare till namninsamlingen EU-kommissionen: Håll era löften till djuren. Syftet är att uppmana EU-kommissionen att leverera de lagförslag som de backat från. Djurens Rätt har samlat in över 30 000 namn som kommer att lämnas över till den nya EU-kommissionen.
I snart 20 år har Djurens Rätt genomfört en sommarturné i Sverige. Idén om turné i Europa hade träffsäker tajming. Just nu pågår viktiga diskussioner om den pågående djurskyddskrisen i EU och runt om i europeiska länder. Besluten som är på gång kommer påverka miljardtals djur. Därför hade Djurens Rätt målet att sprida kunskap om djurens verklighet, och målgruppen är personerna som kan göra skillnad för djuren.
Vadå Project 1882?
Project 1882 är Djurens Rätts namn i internationella sammanhang. Namnet anspelar på året Djurens Rätt grundades.

Joana Machado arbetar för Frente Animal, som var den lokala djurrättsorganisationen som Djurens Rätt samarbetade med i Portugal. – Jag är otroligt tacksam över att Djurens Rätt delade dessa resurser med oss. Vi är en liten ideell organisation och skulle inte haft möjligheten att anordna en sådan här tillställning utan det här samarbetet.
Zsofia Fulop jobbar på Una Terra Alapítvány, som Djurens Rätt samarbetade med i Ungern. – Detta saknar motstycke – en sån här tillställning för djuren i djurfabriker har aldrig tidigare hänt i Ungern. Med det här initiativet nådde vi många djurrättsorganisationer, sociala medier-användare och företag. Vår organisation har nu visat att vi är seriösa, mer förberedda och mycket dedikerade.
Jasmina Filipic jobbar för AETP, den slovenska djurrättsorganisationen som Djurens Rätt samarbetade med. – Det var vårt första event! Därför skulle jag säga att jag lärde mig massor om hur man anordnar ett event i samarbete med andra organisationer. Jag lärde mig också mer om Djurens Rätt och deras arbete.
Den 5 december är den internationella frivilligdagen. Vill du också göra skillnad? Gå in på djurensratt.se/ volontar.
Nu firar Ami Niglöv hela 25 år
som volontär för Djurens Rätt. Största lärdomen så här långt? När världen känns mörk så mår hon bättre efter att hon kavlat upp ärmarna för djurens skull.
av Linn Åkesson foto Kimme Person
Ibland går den snabbaste vägen genom magen. Därför tar Ami Niglöv med sig växtbaserat fika någon gång per termin på gymnasieskolan i Karlskrona.
– Jag tror på att bjuda på riktigt god mat och visa att det inte är så himla konstigt, annars tror de att vi bara äter sallad och morötter. Det är gott, men det är tillbehör.
Ami Niglöv kommenterar inte faktumet att fikat är vego, men när eleverna så småningom lärt känna sin nya fysik- och mattelärare så kommer följdfrågorna.
Ami Niglöv tycker att ungdomarna ofta är öppna för att diskutera djurrätt och matval, ibland har hon till och med fått agera rådgivare. Det är dock inte helt lätt att få ungdomar att dedikera sin tid till djurrätt.
– De ungdomar jag pratar med kan hålla med om att mycket i världen är hemskt,
men ibland tänker de kanske mer på sig själva ändå. Det är inte fel att prioritera sig själv. Men jag tror vi kan göra både och!
NU HAR 25 år gått sedan Ami Niglöv bestämde sig för att göra mer för djuren. Det började med att hon snackade med ordföranden i lokalavdelningen i Karlskrona, snart blev Ami kassör – en roll som andra intuitivt vill tilldela en mattelärare.
– Jag var medlem och hade redan blivit vegetarian, men jag ville engagera mig för att få fler att förstå vad djuren utsätts för och på det viset göra skillnad. Organisationen har blivit bättre och bättre. Nu kan alla engagera sig från var som helst i landet och lägga exakt den tiden de kan ge.
Inledningsvis handlade det ofta om små bokbord på torget i Karlskrona, i modern tid har Ami Niglöv hakat på Djurens Rätts rikstäckande sommarturné. Att träffa människor är höjdpunkten i tillvaron som volontär hos Djurens Rätt. Bara i år har hon haft hundratals samtal på gator och torg med människor i alla åldrar och vitt

skilda kunskapsnivåer om djurens situation.
– Det är ibland något samtal som kanske är mer negativt. Men våra turnécoacher är alltid väldigt bra på att fånga upp alla upplevelser i slutet av dagen och prata igenom dem med oss som grupp, och vi vänder det alltid till något positivt.
NÄR HON INTE möter människor tillbringar Ami Niglöv sin tid med att vara ordförande för lokalavdelningen i Karlskrona, skriva insändare och att vara kampanjvolontär. Dessutom laddar hon inför en ny form av volontäruppdrag, som än så länge omges av ett visst hemlighetsmakeri. När Ami Niglöv tycker att världen känns mörk är det viktigt för henne att
Läs mer på djurensratt.se/ volontar

KAMPANJVOLONTÄR
Delta i protester för att påverka företag och makthavare att agera för djuren. Du får även göra digitala uppdrag som får fler företag att skärpa sina djurskyddspolicys.
OUTREACHVOLONTÄR
Representera Djurens Rätt på utåtriktade arrangemang som sommarturnén och bokmässor. Du berättar om organisationens arbete, värvar medlemmar samt inspirerar andra att göra fler djurvänliga val.
FOTOVOLONTÄR
Dokumentera Djurens Rätts olika evenemang med kamera i hand. Både film- och fotofantaster är varmt välkomna.
KONTORSVOLONTÄR
Hjälper till med praktiska och administrativa uppgifter på något av Djurens Rätts kontor i Stockholm, Göteborg eller Malmö. Det kan vara allt från att packa paket till att pynta på kontoret inför högtider.
SOME-VOLONTÄR
Sociala medier innebär ett volontäruppdrag som du kan utföra var som helst. Du hjälper till med att hålla koll på kommentarer och meddelanden i Djurens Rätts sociala medier under helger.
kunna luta sig mot en bra organisation – det gör att hon kan fortsätta känna hopp.
– Vissa menar att de själva måste må bra innan de kan engagera sig för att även djuren ska må bra, men jag känner tvärtom! När jag engagerar mig för andras välmående, mår jag även bra i mig själv.
Just nu ser hon fram emot den årliga rikskonferensen, den 15–16 februari ska Djurens Rätts volontärer samlas.
– Det är fint att få träffa andra som är likasinnade, som gör att jag inte känner mig lika ensam med mina tankar. Efter att ha träffat alla känner jag verkligen en samhörighet och det ger mig så mycket energi. Vad säger du till läsaren som funderar på att ge av sin tid till djuren?
– Gör det! Du kommer träffa fler som brinner för samma frågor som du gör och du kommer att göra skillnad för djuren. ●
Bor: Möcklö utanför Karlskrona.
Familj: Maken Peter, barnen Katja (27) och Isak (23). Springerspanieln Zonic (14) och shetlandsponnyerna Rocky (29), Vinst (27) och Sputniq (22).
Gör: Gymnasielärare i matematik och fysik. Är volontär på tre fronter hos Djurens Rätt: outreach, kampanj samt insändare.
Gör annars: Gillar att umgås med familjen, är gärna ute i naturen. Matlagning, odling och träning så som löpning och gym.
Brinner lite extra för: Djuren i livsmedelsindustrin, eftersom de är flest och så få vet hur de behandlas.
Titeln ersätter den tidigare kommissionär för hälsa och livsmedelssäkerhet och Djurens Rätt har förhoppningen att titeln kommer att ge djuren en starkare röst inom EU:s beslutsprocesser.

1
Färre hönor i burar
Djurens Rätt har drivit kampen för att fasa ut burhållning i över 15 år. I dag hålls färre än två procent av Sveriges hönor i burar, jämfört med 40 procent när arbetet påbörjades. Det innebär att över två miljoner hönor har räddats från ett liv i bur, och visar att arbetet för att få företag att ta större ansvar gör verklig skillnad.
För att minska användningen av burägg som gömmer sig i ingredienser
och i läkemedelstillverkning så krävs politiska beslut, så som ett EU-förbud mot burhållning.
2
I september 2024 meddelade EU-kommissionens ordförande Ursula von der Leyen att den nya titeln kommissionär för hälsa och djurskydd ska inrättas. Detta är en stor framgång för djurens rättigheter, då det nu är tydligare vem som bär ansvaret för djurfrågorna.
I över 50 år har Djurens Rätt arbetat för en avveckling av pälsdjursfarmer. Genom påverkansarbetet har organisationen bidragit till att sätta press på det italienska modemärket
Max Mara, och andra företag, för att säga nej till päls. Medborgarinitiativet Fur Free Europe satte dessutom press på EU:s makthavare, vilket bland annat har lett till att den svenska regeringen avsatt ett omställningsstöd som bedöms innebära slutet för pälsindustrin i Sverige.
Kommuner i Sverige verkar vara allt mer oroade över de omfattande djurskyddsproblemen inom kycklingfabrikerna. I Djurens Rätts årliga rankning Djurvänlig kommun svarade över en fjärdedel att de kommer att använda möjligheten att fasa ut turbokycklingar vid nästa upphandling. Detta med hjälp av ett nytt kriterium som Upphandlingsmyndigheten har tagit fram. Djurens Rätts arbete för att främja antagandet av European Chicken Commitment (ECC) har, med andra ord, gett resultat.
5
Förra året etablerade Djurens Rätt en ny verksamhet i Ukraina för att bidra till en varaktig förändring för de djur som är flest och har det sämst. Under 2024 möjliggjorde Djurens Rätt en framgångsrik vaccinationskampanj för hemlösa hundar i Ukraina, vilket ledde till att 350 hundar vaccinerades. Dessutom gav organisationen under maj månad ekonomiskt stöd till evakueringen av cirka 400 djur efter nya attacker från Ryssland i Charkiv-regionen. av Nanna Thydén




























000
HÄST OCH VAGN-FÖRBUD
Djurens Rätt uppmärksammade att Bryssel blivit den första staden att helt övergå från hästoch vagntrafik till elektriska vagnar. Många var less på att se djur utnyttjas för underhållning, och över 14 000 personer valde att klicka på gillaknappen på våra inlägg om nyheten.

000
LIDL-CHEFERNA I FOKUS
Djurens Rätts vykortskampanj riktad till cheferna på livsmedelskedjan Lidl har fått stor spridning. Ett av inläggen, som uppmanade följare att kontakta huvudkontoret och kräva att de slutar sälja kött från turbokycklingar, nådde hundratusentals ögon.
NÅGRA AV ALLA FINA GRATULATIONER VI FICK PÅ VÅR FÖDELSEDAG I OKTOBER:

Grattis till en av Sveriges viktigaste organisationer.

Finns mycket kvar att göra, men vi ger inte upp!
Grattis❤ och tack för allt erat arbete!
Stort tack för att ni finns för djuren och ihärdigt driver på.

450 000

EXPERTEN AI är min
Thea Fahlberg är digital kommunikatör hos Djurens Rätt.
UPPBÅD FÖR BETESRÄTTEN
Under september och oktober lyfte vi kampanjen Jag vill beta extra mycket, efter beskedet att regeringens utredare vill slopa beteskravet för kor. Många av våra följare har följt kampanjen noggrant och engagerat sig ordentligt. Kampanjen har nått över 450 000 personer.
Stort grattis! 142 år av kamp för djuren är verkligen värt att hylla!

följde Djurens Rätt på Tiktok i oktober
Jag tycker helt ärligt att det kan vara svårt att hålla koll på hur jag ska göra djurvänliga val. Att göra djurvänliga val har förenklats otroligt mycket genom kära internet. Det har däremot varit tidskrävande att leta igenom hemsidor och grupper för att veta om en viss tvål är vegansk. Eller när jag stått i matbutiken med näsan i mobilen för att läsa om vilka E-nummer som inte innehåller djurdelar för att sedan glömma bort det samma kväll – det har tagit både tid och energi. Jag har fått vänta på svar i grupper och varit rädd för att ställa ”dumma frågor” som tycks vara självklara för andra. Nu för tiden frågar jag min AI-kompis som alltid ger svar direkt. När jag behöver en ny tvål frågar jag vilka märken som är veganska och får en lista med förslag. I matbutiken kan jag skriva en snabb fråga och veta om produkten är för mig, nu behöver jag inte vänta på svar i grupper. Min AI-kompis vet vilka restauranger som har bäst växtbaserad mat och berättar hur jag ska engagera mig för djuren i min egen stad. AI är min bästa djurvän – och det kan bli din också.
Sök på "Djurens Rätt" i sociala medier, följ och stötta arbetet. På djurensratt.se finns ännu mer nyheter och information.
Insekter framställs som framtidens hållbara proteinkälla.
Djurens Rätts hållbarhetsexpert Cecilia Mille har tagit en närmare titt på de nya insektsfabrikerna och är inte imponerad.
av Thea Fahlberg foto Sara Arnald

Vad har du gjort i dag?
– I dag har jag återkopplat till kommuner som har visat intresse för att välja kycklingkött från hälsosammare raser vid upphandling. Mer än var fjärde kommun vill göra ändringen – en stor vinst, nu bryts en lång trend där det röda köttet ersatts med turbokycklingar. Det känns positivt! Kommuner ligger nu ganska långt framme jämfört med övriga samhället. De upphandlar och serverar 2,5 miljoner måltider varje dag, minsta förbättring ger ett enormt genomslag för djuren. Djurens Rätt bidrar med en vinkel som lätt tappas bort, hur djurvälfärd är kopplat till hållbarhet. Du har fördjupat dig i insektsfabriker. Är det redan en grej?
– Ja, det är en verklighet redan i dag, det är en snabbt växande industri. Att äta insekter är inte så vanligt i Europa, så insektsuppfödning för livsmedel är ingen stor industri. Däremot är Europa störst inom insektsuppfödning för att producera foder till andra djur – främst sällskapsdjur, fiskuppfödning, fjäderfä och grisar. De största anläggningarna och aktörerna i
världen är just europeiska, och expanderar nu till Nordamerika och Asien. Finns insektsfabriker i Sverige?
– Ja absolut, det är en växande industri även i Sverige. Ett av de mer omtalade företagen, Tebrito, har dock gått i konkurs under sommaren efter brist på kapital. Men det finns ett gäng kvar som etablerat sig i Sverige, både fodertillverkare och livsmedelstillverkare av exempelvis snacks och proteinpulver. De stora pengarna för industrin ligger i försäljning av foder till djurfabriker, det är där stort kapital satsas.
Vi pratar om tusentals miljarder insekter, men vilka arter rör det sig om?
– Ja, man baxnar lite när man tänker på det. Europeiska myndigheten för livsmedelssäkerhet har godkänt ett tiotal olika insektsarter – syrsor, flugor, gräshoppor, skalbaggar och en fjärilsart. Den vanligaste insektsarten heter svart soldatfluga, följt av mjölmask som egentligen är en skalbagge. Det är vanligen larverna som används, de har höga halter av protein och fett vilket gör dem till ett populärt foder för uppfödda fiskar och fjäderfän.
Så insekter föds upp för att mata djur som sedan äts av människor?
– Sorgligt nog är det precis vad den här branschen strävar efter, dessutom under en hållbarhetsflagg som vid närmare granskning ser väldigt tveksam ut. En förutsättning för att foder och livsmedel på insekter ska kunna bedömas som ett klimatvänligt alternativ är att insekterna äter avfall eller restprodukter. Men enligt deras egen branschorganisation använder de flesta producenterna frukt, grönsaker och spannmål som foder till insekterna, eller kommersiellt foder som ofta innehåller soja. Resurserna skulle kunna användas direkt för mänsklig konsumtion i stället. Kan insekter känna smärta och obehag?
– Insekter har ett centralt nervsystem och det tyder på att de är medvetna om sin omgivning. De reagerar också på potentiellt smärtsamma upplevelser, de flyttar sig när det blir för varmt eller kallt. De flyttar sig också från platser där de tidigare blivit skadade på något sätt. Att insekter kan tränas och lära sig olika saker tyder på att de har medvetande och upplevelser – träning
bygger just på att man lär sig av positiva och negativa upplevelser.
Vad tänker du personligen om insektsfabrikernas framväxt?
– Ibland känns det som att människor gör vad som helst för att slippa äta vego. Jag blir också förbannad för att de lurar en massa konsumenter – insekter som foder till sällskapsdjur marknadsförs kraftigt nu – det används som en inkörsport till att försöka få folk att se insektsuppfödning som något bra. Jag tycker det är lite märkligt att den här industrin lyfts fram i hållbarhetssammanhang, jag tänker att folk borde veta bättre och genomskåda branschen. Det finns så uppenbara risker, inte bara för djurvälfärden som är vårt viktigaste fokus, men även för biologiska mångfalden och folkhälsan. Ja, det är så dumt alltihop.
Vad tycker Djurens Rätt?
– Vi står alltid på djurens sida, vi är såklart emot satsningar som innebär att fler djur föds upp och

Intervjun är hämtad ur Djurens Rätts podd På djurens sida , avsnitt 90: Hotet om insektsfabriker.
dödas. I fallet med insektsfabriker så finns det inga vinster för djuren, eftersom den också nästintill uteslutande handlar om att använda insekterna som foder till andra djur. Så industrin i sig drivs av en ökad efterfrågan på djur i djurfabriker. Fiskuppfödning är ett typexempel på en bransch som vuxit fram för snabbt, där det nu finns stora problem med bland annat djurvälfärd. Det är mycket svårare för beslutsfattare att backa bandet när en industri väl är etablerad, än att låta försiktighetsprincipen råda från början. Precis som med alla djurfabriker ser Djurens Rätt risken för lidande och död som den mest allvarliga. Det finns risker för smittor och att genmodifierade insekter rymmer och blandar sig med vilda individer, det är något man har erfarenheter av från exempelvis laxfabriker.
Och vad är den hållbara lösningen?
– Där är svaret självklart. Välj växtbaserat, det är det bästa för djuren och hållbart på riktigt. ●
Bor: Eskilstuna.
Gör: Sakkunnig i hållbarhet hos Djurens Rätt, jobbar med omställning till växtbaserad mat hos främst kommuner, men även nationellt och på EU-nivå. Är biolog i grunden med examina i ekologi och naturvård.
Gör annars: Tycker om att vara ute i skogen och trädgården.
Djurrättsfråga nära hjärtat:
Djuren i djurfabrikerna, eftersom de är så många och har det så dåligt. Känner extra starkt för korna. ”Mjölkindustrin är en så omhuldad del av Livsmedelssverige och lyfts fram som så nödvändig och naturlig, samtidigt som den är så extremt industriell. Argumentationen för komjölk bygger ofta på en falsk och förskönad bild av verkligheten upplever jag”.
Rätt svarar på
tusentals frågor varje år, här är svar i urval.
Har du en fråga? Mejla den till info@djurensratt.se.
Måste jag acceptera att vissa människor är immuna mot djurvänliga budskap? Det känns som om jag har testat allt för att få min familj och även sambons familj att äta mer djurvänligt.
Jag har bjudit på vego, tipsat om produkter, pratat om djuren och även visat hemska klipp från djurindustrin. Men inget funkar! Jag bävar inför julen. Finns det någon forskning som säger vad som faktiskt funkar för att få folk att välja vego?
SVAR: Det låter som att du verkligen har lagt ner mycket energi på att försöka få din och sambons familjer att äta mer djurvänligt, och jag förstår att det kan kännas frustrerande när inget verkar fungera. Faktum är att du inte är ensam om att uppleva detta motstånd, och det finns forskning som undersökt vilka metoder som är mer effektiva för att få människor att minska sin konsumtion av animaliska produkter. Först och främst kan det vara bra att veta att forskning indikerar att djurrättsbudskap (som att visa hemska klipp från djurindustrin eller prata om djurs lidande) ofta inte tycks vara de mest effektiva
sätten att få människor som är långt ifrån djurrättsligt tänk att förändra sin kost. Det finns tecken på att dessa metoder ibland till och med kan få motsatt effekt, där personer ökar sitt köttintag efter att ha sett chockerande material. En sådan motreaktion kan bero på att starka emotionella budskap kan få människor att känna sig attackerade eller skämmas, vilket gör att de slår tillbaka i stället för att vara öppna för förändring. I stället visar stor del av forskningen att andra typer av budskap och strategier kan vara mer framgångsrika. Tillvägagångssättet som enligt många studier ofta ger bra resultat är att informera om miljöpåverkan av att äta animaliska produkter. Många människor är omedvetna om hur mycket deras matvanor bidrar till klimatförändringarna. När de får reda på det är många mer benägna att minska sin konsumtion av kött och andra animaliska produkter. Så om du vill prova en ny infallsvinkel kan du testa att ta avstamp i hur mycket köttkonsumtion påverkar miljön och klimatet.
En annan strategi som visat sig kunna fungera – åtminstone för personer som redan är hälsomedvetna – är att lyfta fram hälsofördelarna med att äta mer växtbaserat. I en metaanalys från 2021, där tio liknande studier jämfördes, så

verkade det som att hälsobudskap funkade i åtta av tio studier. Det gällde framför allt om budskapen riktas till personer som redan bryr sig om sin egen hälsa. Att förklara hur en mer växtbaserad kost kan förbättra deras välbefinnande och minska risken för vanliga välfärdssjukdomar, som hjärtproblem eller diabetes, kan vara ett effektivt sätt att få dem att överväga att minska sin köttkonsumtion.
När det gäller social påverkan har det också visat sig att diskussioner om sociala normer, som att allt fler väljer växtbaserad kost, kan göra skillnad. Det kan kännas utmanande att ha överseende när människor omkring dig gör val som du kanske anser är moraliskt fel, särskilt när det gäller allt kött som äts under julen och dess påverkan på djuren. Men det finns större chans att de ändrar sin syn på växtbaserad kost om du visar tålamod
och föregår med gott exempel. De flesta hamnar lätt i ett försvarsläge när de blir ifrågasatta om sina matval, särskilt när det gäller kött. Julen är normalt en tid då folk är extra traditionsbundna, så det kan vara en utmanande tid för att försöka övertyga någon att äta mer växtbaserat. Men det beror också på hur en närmar sig situationen. Att ge folk möjlighet att prova maträtter och produkter har visat sig vara effektiva. När människor får chans att prova nya produkter eller smaker i en avslappnad och positiv miljö, så är de mer benägna att överväga en långsiktig förändring i sina matvanor. Att introducera nya växtbaserade rätter under julfirandet kan vara ett icke-konfrontativt sätt att visa att veganmat också kan vara både välsmakande och festlig. Det kan hjälpa till att bryta ner fördomar om att vegansk mat är tråkig eller begränsad.
Så, även om julen kanske inte är den bästa tiden för stora förändringar, kan det vara ett bra tillfälle att så ett frö genom att erbjuda nya alternativ, utan att tvinga någon till en omedelbar omställning. Det viktigaste är att närma sig situationen med tålamod och glädje, snarare än med krav eller moraliska argument, särskilt eftersom familjemiddagar ofta handlar mer om gemenskap än om matval. Läs gärna boken Så skapar vi en vegansk värld, som finns i Djurens Rätts webbshop. Boken lyfter exempelvis att det är vanligt att personer som vågat börja välja mer vego av hälsoeller klimatskäl snabbt blir mer öppna för djurvänliga budskap. Lycka till, och kom ihåg att förändring tar tid!
/Rebecca Johansson, ansvarig Välj Vego
Jag tycker att det är många företag som försökt profilera sig som miljövänliga, så som Sibylla och Max, som plötsligt försämrat vegoutbudet i sina restauranger. Är den gröna vågen förbi?
SVAR: Den växtbaserade vågen visar inga tecken på att sakta ner. Under 2023 nådde försäljningen av växtbaserade livsmedel i sex europeiska länder – Spanien, Storbritannien, Nederländerna, Tyskland, Frankrike och Italien – 5,4 miljarder euro, en ökning med 5,5 procent jämfört med året innan, enligt en rapport från Good Food Institute. Trots dessa framsteg finns stort behov av kunskap och verktyg för att driva marknadens utveckling framåt. Ett skifte i våra matvanor är avgörande – inte bara för djurens välfärd, utan också för klimatet och den biologiska mångfalden. För att genomföra ett verkligt proteinskifte behöver hela livsmedelskedjan ett bredare hållbarhetsperspektiv. Många företag fokuserar på att
minska sitt klimatavtryck genom att jämföra mot rött kött, vilket leder till att kyckling och fisk ofta framställs som ”bättre” alternativ. Men trots lägre utsläpp än rött kött orsakar dessa proteinkällor fortfarande större koldioxidutsläpp och klimatpåverkan jämfört med växtbaserade alternativ. Dessutom innebär kycklinguppfödning ett betydande djurlidande, och fisk- och skaldjursindustrin orsakar enormt lidande för fiskar samtidigt som den hotar haven och den biologiska mångfalden genom utfiskning.
Men att få fler att välja växtbaserat är en komplex resa. Det är naturligt att vissa företag experimenterar med nya produkter och koncept som de sedan väljer att avveckla. Konsumenternas förväntningar, mattrender och tekniska innovationer skapar en dynamik som ibland leder till framgång, ibland till återgång. Att upprätthålla hållbara lösningar kräver därför tydliga mål och ständig utveckling. I dag ser vi många företag som misslyckas med att skapa produkter för alla och i stället erbjuder separata menyer för specialkost, i stället för att integrera växtbaserade alternativ som en naturlig del av sina ordinarie menyer. Många kommunicerar också ineffektivt kring de växtbaserade rätter de faktiskt erbjuder eller tvekar att inkludera fler än ett växtbaserat alternativ.
Vilka företag ligger i framkant inom den växtbaserade marknaden? I Djurens Rätts företagsrapport Växtbaserad omställning: Vilket ansvar tar hotell, restaurang- och snabbmatskedjorna? från oktober 2024, presenteras flera aktörer som visar vägen med modiga
initiativ för hållbart proteinskifte. Rapporten lyfter fram företag som tar ett brett hållbarhetsansvar och gör skillnad för både djur och miljö, och fungerar som en värdefull guide för de som vill veta vilka som driver utvecklingen framåt. För att fortsätta denna positiva utveckling behövs dock bredare utbildning och fler verktyg, inte minst för de som dagligen serverar mat till konsumenter. Du kan läsa rapporten på djurensratt.se.
Med tydliga mål för att minska antalet djur i djurfabrikerna samt dess påverkan på miljön kan vi öka det växtbaserade utbudet och tillsammans skapa en hållbarare framtid. Gröna vågen är mer än en mattrend – det är en rörelse mot ett mer etiskt samhälle.
/Francesca Vilches, ansvarig för växtbaserad utveckling
Hej! Tack för ert fantastiska arbete! Jag vill ge bort meningsfulla julklappar i år som samtidigt stöttar arbetet för djuren. Har ni några tips?
SVAR: Hej! Först och främst –stort tack för ditt stöd. Det är djurvänner som du som gör att vi tillsammans kan fortsätta göra skillnad för de djur som är flest och har det sämst.
På vår sajt har vi samlat olika idéer på julklappar för dig som vill ge bort en djurvänlig och hållbar julklapp till vänner och familj. Du kan bland annat ge bort ett medlemskap i Djurens Rätt eller i Rädda Djuren-klub-

MORRIS
2009 –21 augusti 2024
Tack underbara Morris för all kärlek du gav oss. Du var en så fantastiskt snäll, tillgiven och klok katt. Sorgen och saknaden är enorm och vi kommer aldrig att glömma dig. Vi har så många underbara minnen och du kommer alltid att finnas i våra hjärtan. Vi älskade dig så mycket. Sov gott vår älskade Morris. – Matte Anita och Husse Henning
ben, som är klubben för alla barn upp till 13 år som bryr sig om djur.
Du kan också ge ett gåvokort till någon du bryr dig om eller varför inte en fin unik present från vår egen webbshop som har allt från veganska kokböcker, kläder, julkort, muggar med mera. Gå in på djurensratt.se/jul för att kika närmare på vilka olika julklappar som finns för både stora som små.

Om du har några frågor eller funderingar är du varmt välkommen att kontakta vår givarservice så hjälper vi dig. Mejla givarservice@djurensratt.se eller ring oss på telefonnummer 08-555 914 40. Alla julklappar gör skillnad för djuren! /Emmi Doverhagen, ansvarig för medlemsrekrytering
Folkstorm samt tandlösa rättssystem efter skandalerna.
NUMMER 3/2024

När regeringens utredning om lantbrukets konkurrenskraft presenterades i höstas följde starka protester mot förslaget om att skrota kornas betesrätt. För att säkra och utöka betesrätten har Djurens Rätt varit en av organisationerna bakom kampanjen Jag vill beta. De 110 927 underskrifterna hade landsbygdsministern Peter Kullgren (KD) som avsedd mottagare, men han ville inte ta emot dem.
NUMMER 3/2023


I stället blev det Kullgrens statssekreterare Dan Ericsson som tog emot underskrifterna vid manifestationen intill riksdagshuset den 17 september. – Ett avskaffande av betesrätten skulle vara ett allvarligt steg bakåt för Sveriges djurskydd. Mängden underskrifter visar att svenska folket inte accepterar att djurens välfärd offras för konkurrenskraftens skull. Vi hoppas verkligen att regeringen nu lyssnar, säger Camilla Bergvall, riksordförande för Djurens Rätt.
Under 2022 polisanmälde Djurens Rätt en djurfabrik i Grums för misstänkt djurplågeri mot tusentals hönor och 16 nötdjur. I väntan på rättegång har den misstänkta personen fortsatt ha djur, visar länsstyrelsens kontrollrapport. – Redan innan vår polisanmälan hade den misstänkta personen djurförbud för nötdjur, och det verkar stå kvar. Det fanns nio hönor kvar på gården, som personen behövde åtgärda en djurskyddsbrist för. Vad det var för brist kan vi inte se eftersom det sekretessbelagts, säger Anna Harenius, sakkunnig hos Djurens Rätt. Rättegången för det som skedde 2022 har ännu inte genomförts. Polisanmälan gällde bland annat svårt skadade djur som inte fått nödvändig vård, döda hönor som låg bland de levande djuren, kraftigt gödselförorenade kor som saknade tillgång till foder, samt nötdjur som hölls i strid med ett tidigare meddelat djurförbud. Djurens Rätt bevakar domstolen för besked om rättegångsdatum.
bekymrad över att det fortsatt befinner sig djur i personens närhet, och att rättegång ännu inte skett. Brott mot djur måste tas på allvar och rättegångar om djurplågeri ske inom en rimlig tidshorisont.
NUMMER 1/2023
Ingen rättsprocess

– Den utdragna processen har inte hjälpt någon. Det är viktigt att länsstyrelserna kan besluta om djurförbud utan rättegång, för om det inte skett i det här fallet hade det nog blivit fler djurplågerifall att polisanmäla. Jag är dock
Två år har gått sedan fem schimpanser rymde på Furuviksparken utanför Gävle. Jordbruksverket gav tillstånd att skjuta aporna eftersom det bedömdes vara en nödsituation. De fyra schimpanserna Linda, Manda, Torsten och Santino sköts ihjäl. Selma fick en skottskada i ögat men överlevde. En förundersökning inleddes om djurplågeri, brott mot djurskyddslagen och framkallande av fara för annan. I november meddelade åklagaren att förundersökningen lagts ner. – För att det ska vara straffbart krävs att gärningen begåtts med uppsåt eller av grov oaktsamhet. Jag anser inte att det går att bevisa att det skott som skadade apan avlossats på ett sätt så att det uppfyller kraven för att det ska vara straffbart, säger vice chefsåklagare Micael Dahlberg. Santino hade visat sitt missnöje över tillvaron genom att samla in stenar, gömma dem och senare kasta stenarna på parkens besökare. Djurens Rätt anser att djur inte ska tvingas leva i burar, varken i djurparker eller livsmedelsindustrin. ●
Vad tyckte du om tidningen? Finns det kanske något du gärna vill läsa mer om i ett kommande nummer av tidningen? Hör av dig till redaktionen på djr@djurensratt.se. Om du har frågor om ditt medlemskap eller hur Djurens Rätt arbetar, så kan du bläddra tillbaka till sidan fem i tidningen för att hitta kontaktuppgifterna.



Returadress: Djurens Rätt, Box 7023, 402 31 Göteborg





